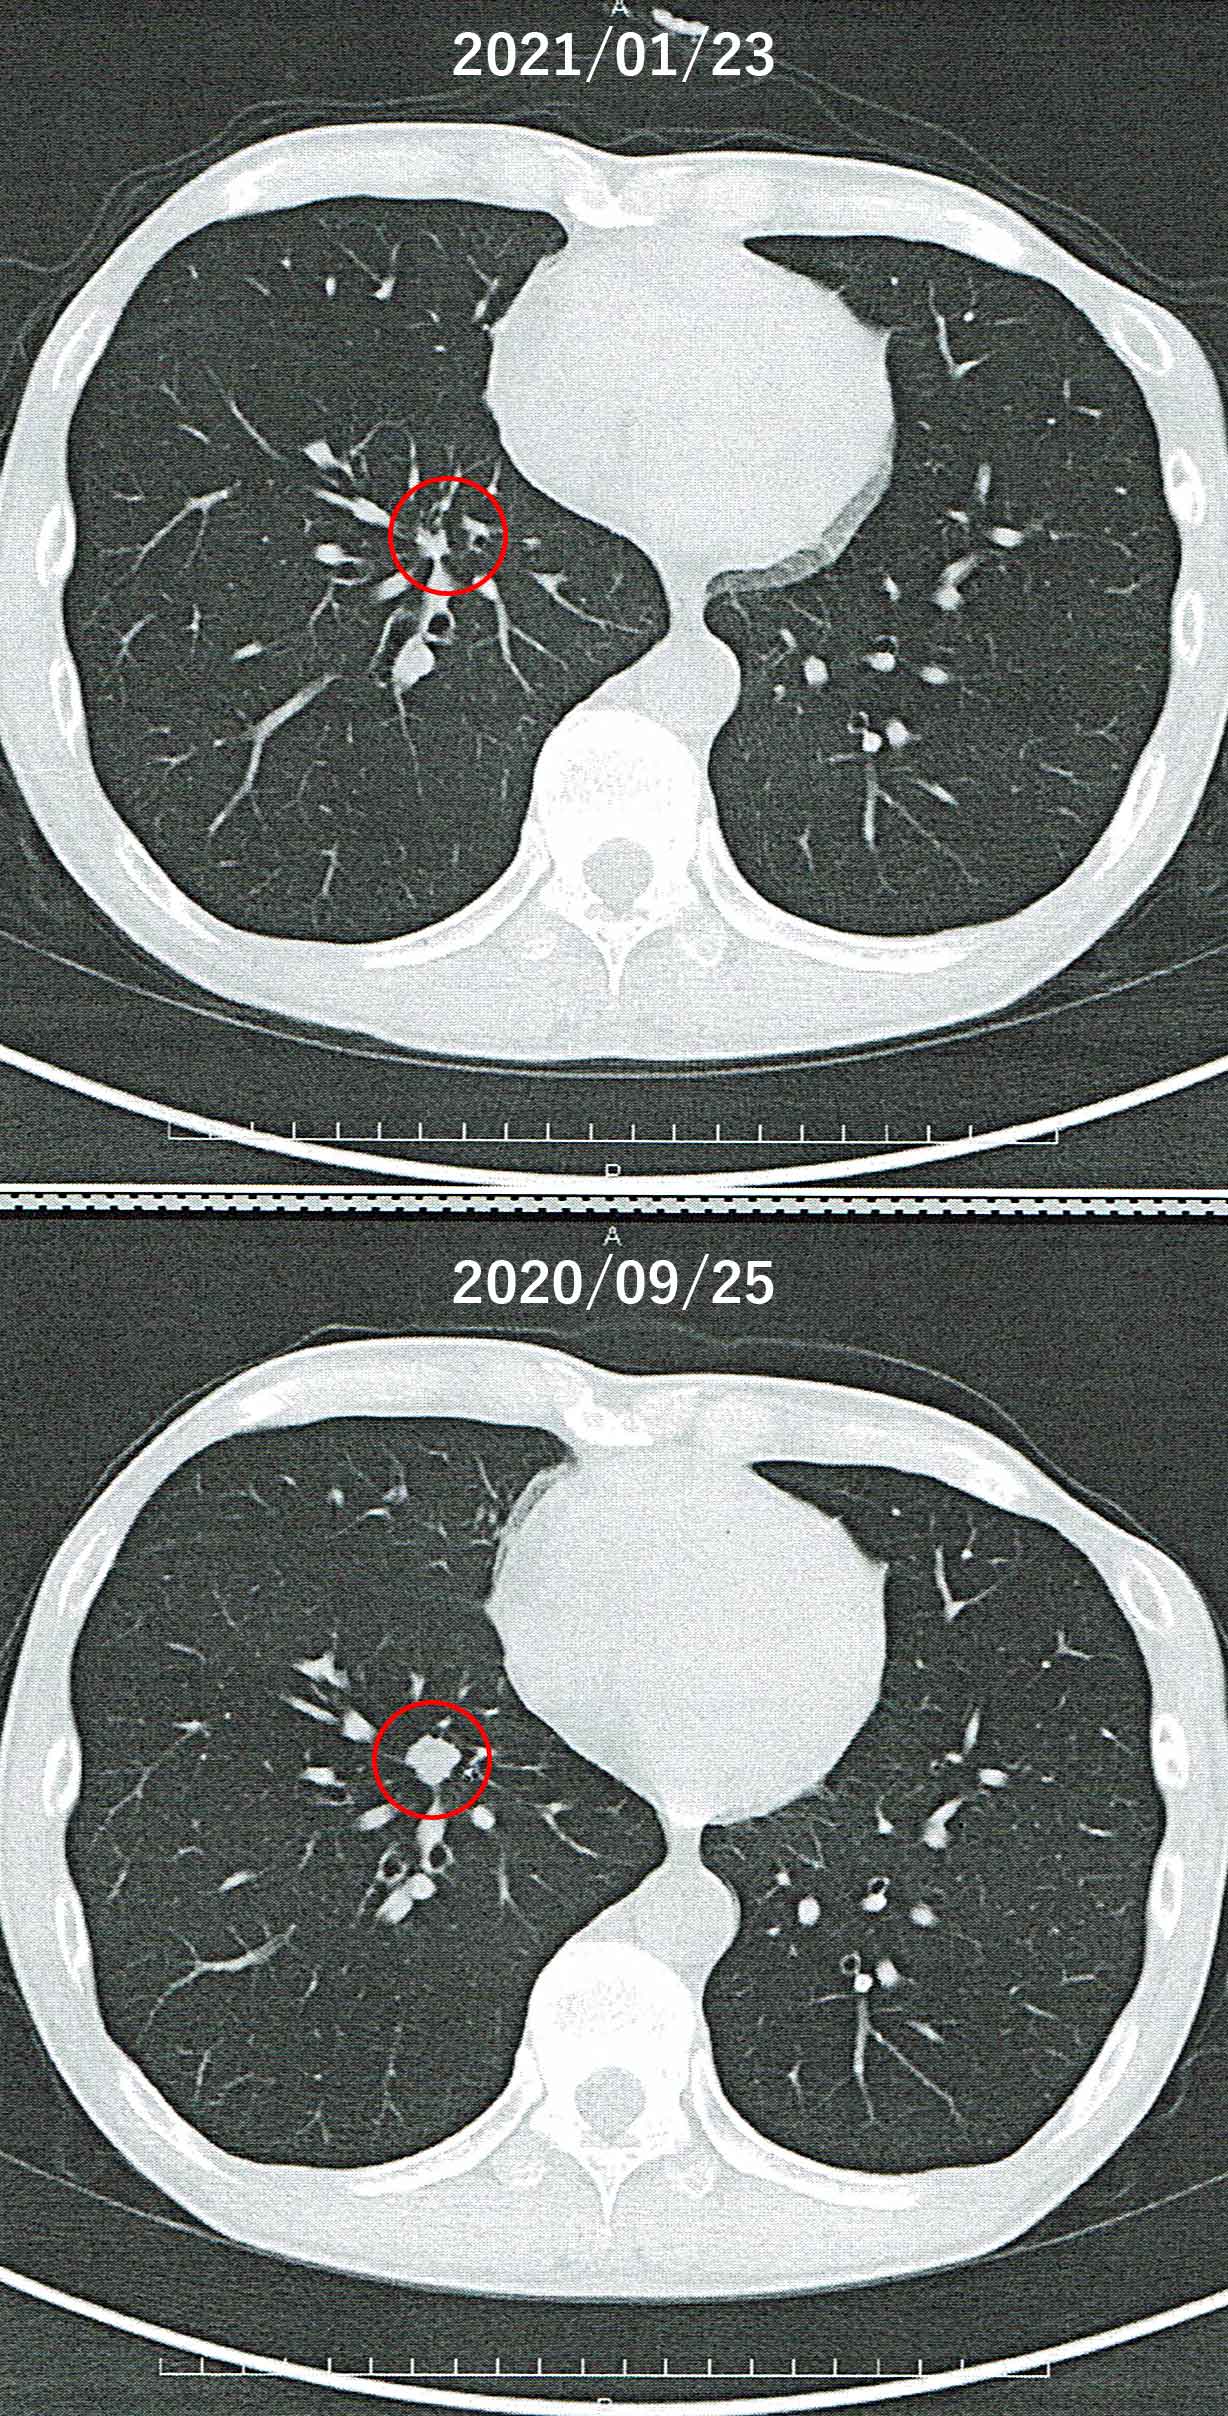
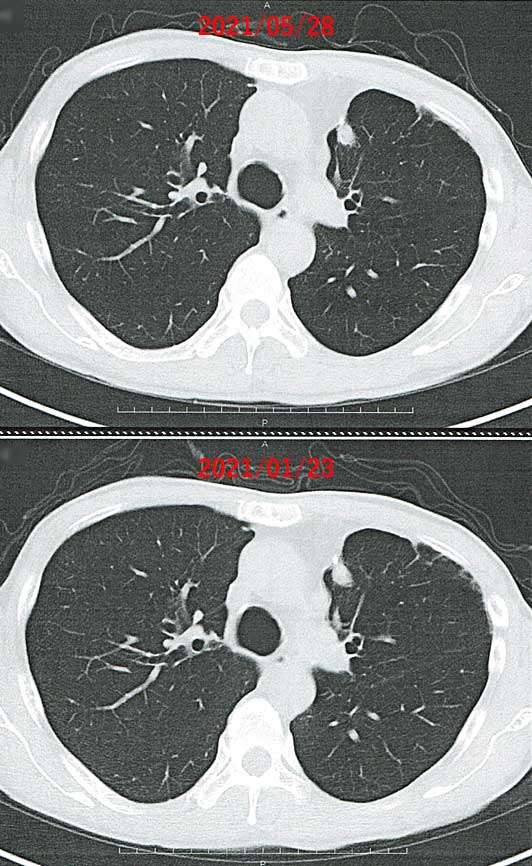

肺癌とイレッサについて
11. 再発
ついに、再発。
| 2019年6月28日(金) |
東邦大学医療センター大森病院にて、胸部CT、血液検査を受けました。 |
||||||||||||||||||||||||||||||||
|---|---|---|---|---|---|---|---|---|---|---|---|---|---|---|---|---|---|---|---|---|---|---|---|---|---|---|---|---|---|---|---|---|---|
| 2019年7月2日(火) |
東邦大学医療センター大森病院にて、先日の胸部CT、血液検査の結果を聞きました。 血液検査は異常無しでしたが、胸部CTでは左肺と右肺に1箇所ずつ小さな結節が見られます。 一見、若干太めの血管のように見えますが、CT画像のスライスを変えると、血管のように連続しておらず、球状であることが分かります。 まだ、とても小さいですが、再発の疑いがありますので、7月13日にPET、8月9日に脳MRIを実施することとしました。 |
||||||||||||||||||||||||||||||||
| 2019年7月13日(土) |
東邦大学医療センター大森病院にて、PETを受けました。 この病院にはPETスキャナーが1台、安静室が3部屋あります。検査時刻に合わせて作られたFDG(放射能を持つブドウ糖に似た物質を含む薬剤)を注射し、それが全身に行き渡るまで、安静室に入って、1時間ほど、水を飲みながら安静にします。 私の隣に入ったのは、高校生くらいの男の子でした。PETを癌以外の検査に用いることは聞いたことが無いので、恐らく骨肉腫のような小児癌でしょう。そういう子供を見ると、「神様なんてものはいないな。あるのはサイコロだけだ。」と思います。癌が何かの報いであるとしたら、癌に見合う悪行を行うには彼らの人生は短すぎます。至るところでサイコロが振られていて、ある確率で癌になっているとしか考えられません。よく、癌などの大病を患うと宗教に走る人がいますが、私の場合は、むしろ、宗教や神頼みはアホくさく感じます。 |
||||||||||||||||||||||||||||||||
| 2019年7月23日(火) |
東邦大学医療センター大森病院にて、先日のPETの検査結果を聞きました。 どこも光りませんでした。すなわち転移無しです。ただ、それだけでなく、再発と思われた左右の肺の影も光らなかった(集積が見られなかった)のです。 ここから、約半年に及ぶ迷走が始まります。 「この2つの影は癌ではないということですか?」 「いえ、癌だと思うのですが、、、」 「癌がPETで光らないことはあるんですか?」 「いえ、光るはずなんですが、、、」 そこで、大分で約1年前の転院前に撮った胸部CTの画像を見てみることにしました。
よく見ると、同じ箇所に小さい影が写っています。そのときから大きくなっていることが分かり、やはり癌である可能性が高まってきました。そこで、
こととなりました。 大分大学医学部附属病院で2018年8月21日に撮影した胸部CT画像に写っている影は意識して見ないと分からないほどの大きさで、これを見逃したことを責めるつもりはありません。しかし、こうした単調だが時間のかかる画像解析は今や人工知能をはじめとするコンピューターが得意とする分野であり、早くそうしたシステムが開発され普及することを願います。 |
||||||||||||||||||||||||||||||||
| 2019年8月9日(金) |
東邦大学医療センター大森病院にて、脳MRI、胸部CT、血液生体検査を実施しました。 |
||||||||||||||||||||||||||||||||
| 2019年8月13日(火) |
東邦大学医療センター大森病院にて、脳MRIと胸部CTの結果を聞きました。 脳MRIは異常無しで、現時点は肺以外への転移は無いと考えられます。肺の再発のみに集中して対策を考えます。 胸部CTは、わずか1ヶ月で1~2mm大きくなっていますので、PETでは光らなかったとはいえ、癌が再発したと考えるのが妥当と思われます。
両画像ともにCT撮影時のスライス間隔は5mmです。1~2mmの精度は無いはずですので、医師が「癌であると結論づけたい」という希望的に判断した可能性があります。しかし、私も癌であることを前提に対処した方が良いだろう、と考えていましたので、医師の判断に「乗っかる」こととしました。実際、後日細胞を採取して癌であることが確認できたので、この判断は正しかったことになります。PETで光らない癌があるということを知る良い機会となりました。 この癌に対してはイレッサが効いていないのは明らかですので、どのような遺伝子変異かを調べてから治療方針を立てることになります。先週実施した血液による生体検査の結果は9月3日には出る予定です。血液中にがん細胞があれば、その解析結果で分かりますが、もし血液中に癌細胞が無ければ、入院して癌細胞を採取する必要が出てきます。 |
||||||||||||||||||||||||||||||||
| 2019年8月15日(木) |
朝起きると、右目の視界に何かふわふわ浮いている(下図)。右目を左右に動かすと、ゆらゆらと形を変える。場所はあまり変わらない。痛みは無い。視野も狭くはない。左目には現れない。右目の中に何かが浮いている感じだ。
タクシーで東邦大学医療センター大森病院に向かう。症状を説明して眼科を受診させてもらうことになったが、お盆の真っ只中というのに、待合スペースには大勢の人が。皆老人で、年をとると目や耳が悪くなるというのを実感する。同じことが我が身にも起こっていることを、このあと知ることになるのだが、、、 いろいろと検査をして、出された診断は後部硝子体剥離。加齢により現れる症状で、硝子体が網膜から剥離することにより、糸くずのようなものが網膜に写る。治療する方法はなく、「病気ではない」と考えられているため、これ以上の処置は行われない。このあと一生、右目の視野に糸くずが浮遊しているのを受け入れなくてはならないそうだ。ただし、網膜裂孔の引き金になることもあるので、注意はしていく必要はあるとのこと。なお、肺がんやイレッサとは無関係と言われた。 |
||||||||||||||||||||||||||||||||
| 2019年9月3日(火) |
東邦大学医療センター大森病院にて、血液生体検査の結果を聞きました。 T790M ヘンイナシ。イレッサ耐性獲得に関連が強いと考えられているT790Mという変異が見られませんでした。医者はこの変異があれば、タグリッソに切り替えようと考えていたそうです。この変異でイレッサ耐性を獲得した肺がんに対して70%の確率で効果が見られるそうです。 「オプチーボはどうですか?」 「オプチーボはそもそもEGFR変異有りの肺がんに関するデータがほとんど無いんです。あってもネガティブなものが多く、遺伝子変異が有る肺がんに効く確率は10%にも満たない、とも言われています。厚生労働省のガイドラインでも使用は推奨されていません。」 ただ、がん細胞そのものが無かった可能性もあるので、CTガイド下生検を検討することになりました。その場合、2泊3日程度の入院が必要です。2週間後に日程調整することになりました。 |
||||||||||||||||||||||||||||||||
| 2019年9月17日(火) |
東邦大学医療センター大森病院にて、呼吸器内科を受診しました。 CTガイド下生検の日程を決めるに至りませんでした。検査技師の見解ではターゲットの左肺の影が「針を刺す的としては小さすぎる」ためテクニック的に外す可能性が高く、もう少し大きくなるまで経過観察することとなりました。そのため、10月11日にもう一度胸部CTを撮影することとなりました。 なお、右肺の影の方が左肺の影よりも若干大きいのですが、周りを太い血管で囲われているため、生検も手術も難しいそうです。 |
||||||||||||||||||||||||||||||||
| 2019年10月11日(金) |
東邦大学医療センター大森病院にて、胸部CTを受けました。 |
||||||||||||||||||||||||||||||||
| 2019年10月15日(火) |
東邦大学医療センター大森病院にて、呼吸器内科を受診し、先週金曜日のCT検査の結果を聞きました。 2つの影ともに1mmほどお大きくなった程度で、「やはりCTガイド下生検を実施するのは難しい」とのことです。ただ、成長していることから癌である可能性は極めて高く、放置するわけにもいかないので、左肺の方だけを胸腔鏡手術で切除して、遺伝子検査を実施し、右肺の方は、その遺伝子検査結果によって選択された抗がん剤および放射線により治療するのが良いのではないか、と提案されました。10月21日に呼吸器外科の先生と話をして、決める予定です。 この約2ヶ月後の2019年12月9日に「あなただけに教えます CTガイド下肺生検のコツ」という本が出版されるくらいなので、医師の腕の問題ではなく、そもそも難しそうである。手技も確立されていないようで、さらにその半年後の2020年6月25日に日本IVR学会から「CTガイド下肺生検の手技に関するガイドライン」の第1版が発行されている。 |
||||||||||||||||||||||||||||||||
| 2019年10月21日(月) |
東邦大学医療センター大森病院にて、呼吸器外科を受診しました。 左肺のみ、生検を目的とした手術をすることにしました。これからしばらくは、その手術のための検査をして、その結果を見て、11月1日に日程を決めることとしました。 |
||||||||||||||||||||||||||||||||
| 2019年10月29日(火) |
東邦大学医療センター大森病院にて、呼吸器内科を受診しました。 再生検を目的とした手術を受けることにした旨をお話ししました。呼吸器内科としては手術前に診察したいとのことですので、とりあえず11月26日に診察の予定を入れ、手術の日程次第で変更することにしました。 |
||||||||||||||||||||||||||||||||
| 2019年10月31日(木) |
東邦大学医療センター大森病院にて、心臓の検査を受けました。 |
||||||||||||||||||||||||||||||||
| 2019年11月1日(金) |
東邦大学医療センター大森病院にて、呼吸器外科を受診する予定でしたが、予約時間を大幅に超過しても呼び出されず、職場に戻らなくてはならない時刻となったため、受診をキャンセルして病院をあとにしました。 |
||||||||||||||||||||||||||||||||
| 2019年11月2日(土) |
東邦大学医療センター大森病院にて、前日キャンセルした呼吸器外科の診察を受診しました。 手術の日程は以下のように決まりました。
4日の手術は全身麻酔を使用するため、家族には、立ち会い、または、常に電話に出られる状態にしておくことが求められます。手術の時刻は前日(3日)の午後に決まるそうです。 退院日は、空気漏れなどが発生しない場合の予定日で、何かあれば延期されることになります。 入院誓約書の連帯保証人(同居家族以外)が未記入の場合は、現金10万円を用意しなければなりません。 |
||||||||||||||||||||||||||||||||
| 2019年11月22日(金) |
東邦大学医療センター大森病院にて、呼吸器外科と麻酔科の診察を受けました。 最初に麻酔科を受診。タブレット端末(iPad)を渡されて、手術と麻酔に関して自習します。30分ぐらいかかります。その後、歯科衛生士による口腔内診察(麻酔中の歯牙脱落防止・周術期肺炎予防が目的)、薬剤師による手術前に服用を中止すべき薬の説明を受けました。イレッサは手術1週間前の11月26日(火)まで服用することになりました。最後に麻酔科医の診察があり、全身麻酔と硬膜外麻酔を行うとの説明を受けました。 周術期とは「一般的には、手術の前後で医療者が関与できる部分という意味で、外科医の診察に基づき手術が決定してから、手術を終えて退院するまでを周術期と呼ぶことが多いです。そして、手術が決まった段階から、麻酔科医をはじめ多職種が関わってリスクを管理していくのが、周術期管理の基本的な考え方です。 硬膜外麻酔に関しては、『麻酔説明書』という冊子に説明があるのですが、転載するのが大変ですので、関東中央病院の以下の説明を参照してください。 呼吸器外科では「ステージⅣで急いで手術しなくてはいけない患者さんが出たので手術をキャンセルして欲しい」と言われました。 「その患者さんには申し訳ありませんが、他の人に打診して頂けませんか。私も抗がん剤が効かない状態で、再発した癌が成長しています。なるべく早く生検を実施して欲しいと考えています。軽視しないで欲しいです。それに、既に11月30日から12月11日まで休暇を取っていて、すべての日程をそれに合わせて調整済みです。1週間前に言われても困ります。それにこんな事があるならば、次回の日程が立てられなくなります。」 「おっしゃることは分かりますが、ここしか入れられるところが無いので、考えて頂けませんか。」 「分かりました。これから日程の再調整ができないかトライして、25日にお返事します。」 生検が遅れて、その結果適切な抗がん剤を投与するのが遅れ、その間に転移でもしたら、彼らは何らかの補償をしてくれるのだろうか? 自分があまりにも軽く扱われているような気がして、憤りを覚えつつ病院をあとにしました。 ところが、この日の夜、呼吸器外科のO先生から直接電話があり、「手術日はそのままとしますが、この日の一番最後の手術とさせてください。ですので、午後遅くになる可能性があります。それから、入院日は12月1日にしてください。」とのこと。日程を再調整する必要は無くなりましたが、その代わり、手術ミスのリスクは若干高まったかもしれません。 |
||||||||||||||||||||||||||||||||
| 2019年11月23日(土) |
東邦大学医療センター大森病院にて、入院に関する説明を受けました。 通常の胸腔鏡下肺葉切除術の場合は手術後7日目退院と説明を受け、念の為12月11日まで休暇をとっておいて良かったとホッとしました。 前回の入院時とは若干違うことがありました。まず、除毛は自分ではしてはいけない、と言われました。傷ができたら手術ができなくなる恐れがあるそうです。また、血栓防止のためのメディカルソックスは持ってくる必要は無い、と言われました。その代わり、ベッドの上で足を動かしたり、散歩をしたりすれば良い、とのことです。 また、「大学病院なので、採取した細胞の研究目的での使用など、学術研究に協力して欲しい」との依頼がありました。大歓迎です。癌になって以来、癌や治療薬に関して分かっていないことがたくさんあることを知り、私はむしろ私をモルモットにしていろいろと実験して、今後の患者さんの役に立ててほしいと考えています。 |
||||||||||||||||||||||||||||||||
| 2019年11月26日(火) |
東邦大学医療センター大森病院にて、呼吸器内科の診察を受けました。 生検の結果が出るまで呼吸器内科としては何もやることが無いようです。 |
||||||||||||||||||||||||||||||||
| 2019年11月30日(土) |
東邦大学医療センター大森病院から「明日(1日)10:30に3号館1階の救急受付に来て、入院して下さい。」と電話がありました。 |
||||||||||||||||||||||||||||||||
| 2019年12月1日(日) |
東邦大学医療センター大森病院に入院しました。 4人部屋です。レイアウトは、大森赤十字病院とほぼ同じです。標準フォーマットのような物があるのでしょうか。窓際のベッドで、遠くに富士山が見えます。
すぐに、心臓、肺機能、血液、尿の検査をして、肺に関しては、スライス間隔1mmのCTスキャンを実施しました。通常は5mmですので、より正確にがん細胞の大きさ・様子を把握することができます。 呼吸器外科の若い医師が深部体温を測定しに来ました。股関節の奥の動脈まで針を指して測定するのですが、なかなかうまくいきません。痛点を上手に外しているのか、鋭い痛みは無いのですが、不快な鈍痛があり、できれば手短に終わらせて欲しいところです。左足の股関節で悪戦苦闘して、結局うまく行かず、「夕方また来ます」と言って立ち去って行きました。その後、夕方に右足の股関節で再挑戦して、今度は無事に測定できました。練習してきたのかな。結果は異常無しとのことです。 万歩計と歩数記録表を渡されました。 「今日から病院内を歩いて下さい。寝る前に1日の合計歩数を記録して下さい。手術後も一般病棟に戻った日から歩いてもらいます。手術前と同じように歩けるようになることが目標です。6,000歩以上を目安にして下さい。地下に5号館へ行く渡り廊下があるので、そこなどはお勧めですよ。」 とりあえず、2回に分けて、合計8,000歩歩きました。地下の渡り廊下は、まったく混雑しておらず、私以外に歩いている患者さんは1人だけでした。 |
||||||||||||||||||||||||||||||||
| 2019年12月2日(月) |
執刀医の呼吸器外科のO先生から、下図の資料を使用した手術内容の説明を受けました。 昨日のスライス間隔1mmのCTスキャンの結果、左肺のがん細胞の大きさは9mm、右肺の方は12mmです。 前回の胸腔鏡下肺葉切除術のときに開けた3箇所の穴のうち、2つを再利用します。上の方にある穴は5cm~8cmぐらいにまで拡張します。前回の手術で補強のためにシートを使用しているのですが、それが胸膜と強く癒着しているため、手を入れて引き剥がす必要があるためです。この引き剥がしによって、ある程度出血が予想されますが、輸血するほどではないとのことです。血液製剤は使用します。 資料には「肺がんに対する手術での平均的な死亡率は1-2%と言われています。」と書かれていますが、この手術の死亡率は0.3~0.4%と説明を受けました。とても低いです。肺瘻(はいろう、空気漏れのこと)になった場合は、ドレーンが抜けず、入院期間を延長する可能性があります。膿胸になった場合は再手術が必要となります。今回は、リンパ節を取るわけではないので、反回神経麻痺は極めて起こりにくいと言えます。
肺機能が一般の人に比べて低いためウルティブロを吸引して気管を拡張することになりました。 病室でパソコンを使用して良いということなので、預託金300円を支払ってLANケーブルを借りたのですが、病室のコネクタにつなげても信号が来ていないようです。看護婦さんに聞いてももちろん分からず、結局断念して、スマホのテザリングを使うことにしました、 隣のベッドの人は何かのドラマを楽しみにしていたようです。お見舞いに来ていた奥さんが「ビデオ消しちゃった」と言うと、軽く喧嘩になっていました。 |
||||||||||||||||||||||||||||||||
| 2019年12月3日(火) |
明日の手術は、午後3時からとなりました。この日最後の手術で、前の手術次第で、時刻は大きく前後する可能性があるので、家族には12時に来て待機しておいて欲しい、と言われました。 |
||||||||||||||||||||||||||||||||
| 2019年12月4日(水) |
手術。 手術にはまったく関係ありませんが、快晴です。
朝から食事は抜きで、生理食塩水の点滴のみです。
手術後は集中治療室に入るので、病室を空けなければならず、荷物をまとめて、2号館入口のコインロッカー(100円)2つに預けました。 手術は予定通りでした。 2時頃、家内と一緒に手術室エリアに移動して、そこで、まず、手術チームの紹介と簡単な手順の説明を受けます。その後、私が手術室に入ったあと、家内には手術の内容の詳しい説明があったそうです。 手術室に入ってからは、全身麻酔以後、集中治療室のベッドで目を覚ますまで、記憶がありません。 手術が上手だったのか、前回の手術に比べて、ダメージが格段に少ないです。まず、前回は激しい肩こりのようになり、首や腕を動かすのがとてもつらかったのですが、今回は全くありません。手術時間が短かったのかもしれません。また、前の手術跡を広げているはずなのですが、神経を切断しないように切ったのか、痛みが前回よりも少なく感じます。そのため高熱にうなされることもなく、痛み止めをそれほど追加することもなく、良く寝ることができました。 |
||||||||||||||||||||||||||||||||
| 2019年12月5日(木) |
痛み止めが効いているのか、手術翌日とは思えないくらい痛みがありません。 ベッドに寝ながらレントゲン写真を撮るのですが、歩いてレントゲン室に行けるくらいです。朝食も完食しました。 看護学校の生徒さんに体を拭いてもらい、医学部の学生さんに問診をしてもらって、一般病棟に戻りました。 病室に戻ると早速看護師の付き添いのもとウォーキングです。ただし、万歩計が足りなくなったとのことで、万歩計無しでした。 「スマホをお持ちなら、スマホで歩数を測定して下さいね。この階を8周するとだいたい1000歩です。血中酸素濃度を見ながら歩いて下さいね。90%を切ったら立ち止まって、90%を上回るまでじっとして下さい。」 確かに、80%台になると、軽い貧血のような感じがします。 スマホが必要とのことで、コインロッカーに預けた2つの荷物のうち、スマホの入っている1つを取ってきました。ところが、それを見咎めた看護師から「今日はこの階だけにして下さい!」と怒られました。この日のうちに4,000歩歩きました。 点滴の落ちが悪く、管が挿入されている周辺が腫れてきたので、点滴を別の場所に刺し直してもらいました。この点滴は手術室の中で刺したもので、確かに、なかなかうまく行かず、「この人下手だなぁ」と思った記憶があります。 |
||||||||||||||||||||||||||||||||
| 2019年12月6日(金) |
ドレーンを取り、縫合しました(下図の下の方)。担当は、深部体温の測定に失敗した若い医師です。ちょっとキツすぎるような気がします。実際、上の大きな傷よりも治るのが遅かったです。
点滴も、昨日せっかく刺し直してもらって快適になったところですが、17時を最後に管を抜きました。このとき、左腕の手術時のマーキングがまだ残っていることに気づきました。間違いを防止するためには大切なことですね。
この日は、残りのもう一つの荷物をコインロッカーから引き揚げてきて、合計6,000歩歩きました。昨日私を怒った看護師は、スタスタ歩き回っている私を見て、「もうすっかり大丈夫なようですね、、、」と言葉を失っていました。 |
||||||||||||||||||||||||||||||||
| 2019年12月7日(土) |
血液検査、胸部X線、肺機能検査を実施しました。その結果を踏まえて、呼吸器外科の先生が傷口の状況を確認し、「明日以降いつでも退院して結構です。」と言われましたので、家内と相談して、明日10:00に退院することにしました。 予定通りとはいえ、驚異的な回復力のようです。 |
||||||||||||||||||||||||||||||||
| 2019年12月8日(日) |
10:00 東邦大学医療センター大森病院を退院しました。 白血球に続き、CRPも減少してきているので、大丈夫だそうです。 傷に細菌が入り増殖すると、近くの血管から白血球が出てきて細菌を貪食し、同時にサイトカインを放出します。サイトカインにより、より多くの白血球が呼び寄せられ、肝臓でCRPが合成されます。CRPは細菌凝集を起こし、白血球に捕捉されやすくなります。 ウルティブロを吸引しても肺機能の改善は見られなかったので、今あるものを吸引し終わったら終了することになりました。イレッサをは再開し、今回の生検の結果が出るまでは継続することになりました。その他、以下の薬が処方されました。
今後2ヶ月間、可能であれば3ヶ月間は、激しい運動、重いものを持つこと、飛行機に乗ることは禁止です。 食事は普通にとって大丈夫です。 傷の部分は毎日せっけんを使って手で撫でるように洗います。上の傷は接着剤が自然に剥がれてくるそうです。下の傷は、糸と衣服が擦れると良くないので、上からカーゼで保護する必要があります。目的が衣服と擦れるのを防止することですので、消毒する必要はありません。「その代わり、洗うときにせっけんをよくゆすいで下さい」と言われました。経過が良ければ、次回の16日の診察の際に抜糸することになりました。 入院中の病院食を以下にすべて示します。
|
||||||||||||||||||||||||||||||||
| 2019年12月16日(月) |
東邦大学医療センター大森病院にて、呼吸器外科を受診しました。 上の方の傷には大きめのガーゼをかぶれにくい絆創膏で留めて覆い、下の方の傷は四角い防水シートで覆っていたところ、恐らく、上の方は手術用の接着剤に、下の方は防水シートに、それぞれかぶれてしまいました。
このため抜糸には至らず、退院時に処方してもらった薬に加えて、外用薬のゲンタマイシン硫酸塩軟膏0.1%「F」を処方してもらいました。 |
||||||||||||||||||||||||||||||||
| 2019年12月17日(火) |
東邦大学医療センター大森病院にて、呼吸器内科を受診し、生検の結果を聞きました。 まず、採取した細胞はがん細胞でした。ここまでは想定通りです。生検をやって正解でした。その遺伝子変異の検査結果は下表の通りでした。
T790M ヘンイミトメズです。 困りました。お医者さんも困っています。すなわち、耐性の原因となると考えられている遺伝子変異が無いにも関わらず、がん細胞にイレッサ耐性が現れたことになります。 「実は、イレッサ耐性の40%は、このパターンなんですよね。」 (聞いてないよ) 「こうした場合は、タルセバならば効く可能性があります。試してみませんか?」 他に選択肢はありませんので、タルセバを試してみることにしました。お医者さんに処方箋を書いてもらい、お薬サポート外来に立ち寄ってから帰ることになりました。 お薬サポート外来では、薬剤師が、処方された薬の服用方法や副作用などを説明してくれます。 まずタルセバの標準は150mg錠なのですが、今回は100mg錠が処方されています。薬剤師が呼吸器内科の先生に問い合わせたところ、「副作用が心配なので少なめにスタートしたい」とのことで、100mg錠のままとなりました。ちなみに、25mg錠というものもあり、細かく調整できるようになっているそうです。 毎日空腹時に服用する必要があります。すなわち、服用する前後1時間以上開けて食事をしなければなりません。「一番楽なのは起床時に服用して、朝ごはんをその1時間後以後に摂るという方法です」ということですので、この方法を採用することにしました。 副作用はイレッサとほぼ同じで、以下のような出現確率です。
下痢が激しい、皮膚がかゆくてたまらない、などの理由で服用を中止する人が少なからずいるそうです。消化器の粘膜は皮膚と連続しており、どちらも「皮膚の炎症」とのことです。表皮の場合は保湿や直射日光を避けるなど対処方法はあるのですが、消化器の粘膜の方はどうしようもないようです。 もちろん、肝機能障害と間質性肺炎も怖いので、これらに関しては、次回の28日に、前者は血液検査で、後者はレントゲンで確認することになっています。 それから、クラリスロマイシンという薬を併用してはいけない、と言われました。代謝がうまく行かなくなり、血中濃度が高くなり、副作用が強く出る可能性があるそうです。 |
||||||||||||||||||||||||||||||||
| 2019年12月18日(水) |
夕方、それまで元気にしていたのに、突然悪寒がして、体がだるくなりました。 帰宅して熱を測ると38.5度でした。 |
||||||||||||||||||||||||||||||||
| 2019年12月19日(木) |
東邦大学医療センター大森病院の呼吸器内科を急遽受診しました。 検査の結果、インフルエンザA型です。「これから5日間自宅隔離です。」と言われました。後日、呼吸器内科の先生から、「手術後で抵抗力が弱まっていたので、退院時に予防接種をすればよかったですね。」と言われました。 イナビルを処方してもらい、薬局で吸入しましたが、吸入するときにむせてしまったせいか、ほとんど効果を実感しませんでした。熱を下げるわけではなく、ウィルスの増殖を抑え、自己治癒力で回復を促すことを目的とした薬なので、自己治癒力が弱い状態では意味が無いのかもしれません。おかげで、下図のように3日間高熱が続き、辛かったです。
|
||||||||||||||||||||||||||||||||
| 2019年12月28日(土) |
東邦大学医療センター大森病院にて、胸部X線撮影、血液検査を実施し、呼吸器外科、お薬サポート外来を受診しました。 まず、手術の傷跡です。 防水シートをやめたところ、かぶれがすっかり無くなり、肌の状態は格段に良くなりました。縫合部分は、まだ少し血がにじんでおり、また、皮下脂肪が白く飛び出してきています。縫合の仕方は美しくはありませんし、締め付け過ぎのような気がします。縫合ではなく、接着剤の方が良かったように感じます。それでも、抜糸することになりました。
次にタルセバの副作用です。 胸部X線で間質性肺炎はみられず、血液検査の肝臓の数値は正常で、肝機能障害も見られません。 下痢もそれほどひどくありません。イレッサのときは毎日軟便でしたので、むしろましなくらいです。
皮膚の発疹も、足にニキビ様の発疹がいくつかできる程度で、痒くも痛くもなく、大したことはありません。
|
||||||||||||||||||||||||||||||||
| 2020年1月31日(金) |
東邦大学医療センター大森病院にて、血液検査、胸部CTを実施し、呼吸器内科、お薬サポート外来を受診しました。 右肺のがん細胞は、タルセバ服用前に比べて小さくなっているように見えます。タルセバを継続することにしました。
両画像とも、スライス間隔は5mmです。 お薬サポート外来では、下記のように、以前から聞いていることを繰り返すだけなので、この日を最後にやめることにしました。
|
||||||||||||||||||||||||||||||||
| 2020年2月3日(月) |
東邦大学医療センター大森病院にて、胸部X線撮影を実施し、呼吸器外科を受診しました。 左肺に溜まった水も抜け、左肺も十分に膨らんできています。
抜糸した傷も治癒しました。皮下脂肪が無いので、下が透けて赤く、乾燥しています。
|
||||||||||||||||||||||||||||||||
| 2020年3月24日(火) |
東邦大学医療センター大森病院にて、胸部CTを撮影し、呼吸器内科を受診しました。 下の画像は、スライスの位置が異なっているように見えますが、3月24日の画像の中で、がん細胞がなるべく大きく映っているスライスで比較しているためです。すなわち、明らかにがん細胞は縮小しているように見えます。タルセバを継続します。
|
||||||||||||||||||||||||||||||||
| 2020年5月6日(水) |
夕刻、東邦大学医療センター大森病院 呼吸器外科のO先生より電話があり、「今、病院に来るのをなるべく控えて欲しいので、特に体調などで気になるところが無ければ、この電話をもって呼吸器外科の治療は終了としたい」とのこと。ちょうどこのとき、最もコロナウィルスに罹患するリスクがあるのは病院であると考えており、「特に気になる症状等はありませんので、終了ということでお願いします。」と即答しました。 後日、調べてみると、4月下旬から5月上旬にかけて、東邦大学医療センター大森病院の職員4名がPCR検査陽性となったとのことでした。 下の画像は、5月7日に撮影した手術痕である。よく見ると、一番下の手術痕は再利用されておらず、新しいところに穴が空けられていたことが分かりました。結構いい加減です。
|
||||||||||||||||||||||||||||||||
| 2020年5月26日(火) |
東邦大学医療センター大森病院にて、胸部X線撮影を実施し、その後、呼吸器内科を受診しました。 胸部X線では1cm程度の腫瘍の成長の観測は難しいところではあるが、判断できる範囲で特に異常は見られないので、タルセバを継続することになりました。 |
||||||||||||||||||||||||||||||||
| 2020年7月21日(火) |
東邦大学医療センター大森病院にて、血液検査、尿検査、胸部CT撮影(造影剤無し)を実施しました。 |
||||||||||||||||||||||||||||||||
| 2020年7月28日(火) |
東邦大学医療センター大森病院にて、呼吸器内科を受診し、先週の検査の結果を聞きました。 血液検査は異常無し。胸部CTで見る右肺の腫瘍の状態は、下図のように、4ヶ月前に比べて大きくなっていないものの、小さくなってもおらず、先生曰く「タルセバでなんとか抑えられている状態」とのこと。
3月24日の画像の方が全体的に大きいので、実サイズとしては7月21日の方が大きく見えないこともない。その点を医師に質問すると、「スキャンの間隔が5mmのため何とも言えない」とのこと。 「急いで対処しなければならない状況ではありませんが、2ヶ月後にもう一度CTを撮りましょう。それで、成長が見られるようであれば、サイバーナイフで除去することを検討しましょう。それまではタルセバの服用を続けましょう。」ということになりました。 「イレッサのときには見られなかった副作用があるんですが。まず、体毛が薄くなりました。それから、鼻の表面から出血するようになりました。」 「どちらも聞いたことが無いですね。」 ここで、タルセバの副作用と思われる症状をまとめておきます。 1. 発疹
2. 顔、特に鼻の頭(表面)からの出血
3. 足の甲の汗疹 4. 体毛が薄くなる
5. 下痢
最後に「コロナにかからないように注意して下さいね。」と言われました。 「肺がん患者だからですか?」 「いえ、肺の状態は、これほどの小さい腫瘍であれば、普通の人と同じと考えて良いでしょう。ただ、歳が歳ですので。」 一番危ないのは病院の呼吸器内科だよなぁ、今日も待合室でゴホゴホ咳してる人がいたし、と思いつつ、病院をあとにしました。 |
||||||||||||||||||||||||||||||||
| 2020年9月25日(金) |
東邦大学医療センター大森病院にて、血液検査、尿検査、胸部CT撮影(造影剤無し)を実施しました。 |
||||||||||||||||||||||||||||||||
| 2020年9月29日(火) |
東邦大学医療センター大森病院にて、呼吸器内科を受診し、金曜日に実施した血液検査、尿検査、胸部CT撮影(造影剤無し)の結果を聞きました。 血液検査は異常無しです。 尿検査で血尿(尿検査で潜血が2+)が見られましたが、「タルセバの副作用と考えられる」とのことでした。 そのタルセバですが、既に効果が薄れているか効かなくなっていると思われ、CTの画像を見ると、右肺の腫瘍が少し大きくなってきています。放置するわけには行きませんので、サイバーナイフという放射線治療を受けることにし、設備のある済生会横浜市東部病院を紹介してもらうこととなりました。
タルセバは多少は効いている可能性がありますので、服用を継続することとしました。 |
||||||||||||||||||||||||||||||||
| 2020年10月1日(木) |
東邦大学医療センター大森病院に、紹介状を取りに行きました。 東邦大学医療センター大森病院の先生からは「放射線科かサイバーナイフのところに電話をして予約してください」と言われましたので、済生会横浜市東部病院に電話をしたところ、「予約は受けていませんので、8:30から11:00の間に1階の総合受付まで来てください」と言われました。 |
||||||||||||||||||||||||||||||||
| 2020年10月11日(日) |
真っ黒の粘性のある下痢便が1回出ました。十二指腸潰瘍が疑われますが、この日が日曜日ということもあり、様子をみることとしました。 翌日以降はいつもの色の下痢便でしたので、この件で病院に行くことはありませんでした。 |
||||||||||||||||||||||||||||||||
| 2020年10月13日(火) |
紹介状を持って済生会横浜市東部病院に行き、呼吸器内科と放射線科を受診し、サイバーナイフの治療の日程を立てました。
|
||||||||||||||||||||||||||||||||
| 2020年10月22日(木) |
済生会横浜市東部病院で、サイバーナイフ治療のための金マーカーの留置を行いました。 サイバーナイフは呼吸を止めずに行います。そのため、呼吸のたびに患部が動きます。その動きに追随して患部に放射線ビームを当てるために、肺の動きをトラックする必要があります。そこで、肺に小さい(直径1.5mm)金の粒を置き、それをX線で観測しながらビームの方向を調整します。この金の粒を金マーカーと呼びます。 吸引式の麻酔で喉に麻酔をかけ、内視鏡を使って、金マーカーを4~5個留置します。留置後サイバーナイフ治療まで数週間ありますので、生活している中で金マーカーが無くならないように、なるべく奥の肺胞に留置します。ギリギリを攻めるので肺胞を突き破るリスクがあると説明を受けました。だからといって、やめるわけにも行かないのですが。また、一度留置すると、ランニングしても外れることはなく、一生残るのだそうです。そのために、人体に害の無い金を使うそうです。死んで火葬したあとに回収するのを忘れないでください。 多少違和感はありましたが、30分ぐらいで留置は無事終わりました。その後、麻酔が抜けるまで看護婦さんたちがいる部屋で1時間ほど安静にしているのですが、その間、遠くから「モガーッ! フガーッ!」「じっとしてください!」「落ち着いてください!」という声が聞こえます。しばらくして帰ってきた看護婦さんが「おじいさん、意外と力が強かったね」と言っていたことから、同じような処置を受けたお爺さんが、痛みのためか暴れたようです。 麻酔をしているので気付いていないのですが、恐らく肺や気道を傷つけているのでしょう。この日の夜、37.9度まで発熱しました。この熱は、翌日まで続き、翌朝でも37.5度で、翌夜にようやく36.6度まで下がりました。 |
||||||||||||||||||||||||||||||||
| 2020年10月28日(水) |
朝、済生会横浜市東部病院から電話がありました。 「今日、放射線科の検査が予定されていると思うのですが、CTの調子が悪くなってしまって、これから業者の人を呼ぶんですが、直らない可能性がありますので、今日の予定はキャンセルさせてもらえないでしょうか?」 「おたくの病院まで片道1時間半かかるので、少なくとも往復3時間、時間を確保しなくてはならないんです。あいにく、サイバーナイフの11月9日まで、そのような時間が取れる日が無いんですが、、、」 「分かりました。では、お昼頃の状況で、今日実施できそうかどうかをご連絡します。もし、実施できない場合は、サイバーナイフの日程も含めてスケジュールを立て直しましょう。」 サイバーナイフは3日間連続で行う必要があるため、リスケジュールとなると、翌年以降に持ち越しとなりそうです。なるべく早く受けたいと思いますので、なんとかこの日のうちに検査を実施したいところです。CTが直ることを祈って待つしかありません。 2時頃、病院から「CTが直りましたので、すぐに病院に来てください」と電話がありました。ほっと一安心です。すぐに支度をして病院に向かい、無事CT検査を受けました。検査の結果、サイバーナイフを受けるのに問題無しとのことです。 |
||||||||||||||||||||||||||||||||
| 2020年11月9日(月) |
済生会横浜市東部病院で、サイバーナイフ治療を受けました。その1日目です。 サイバーナイフは、放射線治療です。放射線で癌細胞を殺すためには放射線を患部に一定以上の線量照射する必要があるのですが、ただ普通に照射したのではまわりの正常な細胞にも同様の線量が照射されるため、その副作用を懸念すると、十分な線量を照射することができません。そこで、放射線ビームをいろいろな方向から患部に照射し、合計の線量が患部だけ一定以上になるようにしたものがサイバーナイフです。 そのため、ビームが確実に患部を通るように照射しなければならないのですが、肺の場合、呼吸にしたがって肺が動き、同様に患部が動きますので、その動きをトラックする必要があります。そのトラックのために、患部の周囲の肺胞に金マーカーを留置し、その動きをX線で観測しながら、ビームの照射方向を変えて行きます。 サイバーナイフの治療室の平面図と側面図を下に示します。天井に2箇所X線の発信器があり、治療台の脇に、受像器があります。
治療は1時間程度なのですが、とても寒く、途中でトイレに行きたくなってしまいました。コールボタンを押して中断してもらい、トイレに行って再開したのですが、なかなか照射が始まりません。医師が治療室に入ってきて、「ちょっと機械の調子が悪くなってしまったので、今再調整をしています。このまましばらく待ってください。」と言われました。結局、予定より45分ぐらい余計にかかって1日目は終了しました。若干疲れた感じはしましたが、特に具合が悪くなるようなことはありませんでした。 また、サイバーナイフの治療費をできればこの日に、できれば3日目までに、全額支払ってほしいと言われましたので、この日に支払いました。 |
||||||||||||||||||||||||||||||||
| 2020年11月10日(火) |
サイバーナイフ治療の2日目です。 1日目にトイレに行って中断し、機械のトラブルに見舞われたので、この日は毛布を1枚余計にかけてもらって、1時間トイレに行くことなく、連続して治療を受けることができました。 治療後、放射線科の医師の診察があり、どのようにビームを照射したのか、画面を見ながら説明を受けました。そのスクリーンショットを以下に示します。患部にだけビームが集中するように、いろいろな角度から照射していることが分かります。こうした治療をしたことを東邦大学医療センター大森病院にも報告されるそうです。
ただ、同時に放射性肺炎という副作用がまれに発症すると説明を受けました。治療前ではなく、治療中に言われてもなぁ、と感じましたが、治療前に言われてもサイバーナイフをやめるつもりはなかったので、結果的には同じかもしれません。サイバーナイフ治療後すぐに発症するのではなく、2ヶ月後~半年の間に発症するようです。普通の肺炎と同じような症状がでるので、コロナによる肺炎と見分けがつかないかもしれません。 |
||||||||||||||||||||||||||||||||
| 2020年11月11日(水) |
サイバーナイフ治療の3日目(最終日)です。 慣れたので淡々と進み、その後の診察もなく、支払いもなかったので、あっさりと終わりました。具合が悪くなるようなこともありません。 |
||||||||||||||||||||||||||||||||
| 2020年11月24日(火) |
東邦大学医療センター大森病院の呼吸器内科を受診しました。 サイバーナイフの効果が見られるのも、副作用が見られるのも、治療後2ヶ月後以降なので、1月にCTを撮って見ることになりました。それまでは、タルセバを服用し続けます。 |
||||||||||||||||||||||||||||||||
| 2021年1月23日(土) |
東邦大学医療センター大森病院にて、血液検査、尿検査、胸部CT撮影(造影剤無し)を実施しました。 |
||||||||||||||||||||||||||||||||
| 2021年1月26日(火) |
東邦大学医療センター大森病院にて、呼吸器内科を受診し、土曜日に実施した血液検査、尿検査、胸部CT撮影(造影剤無し)の結果を聞きました。 血液検査・尿検査の結果は異常無しです。 問題は胸部CT撮影(造影剤無し)の結果です。 サイバーナイフ治療の結果、右肺の腫瘍はだいぶ小さくなりました。残っているのは「やけどの痕のようなもので、死んでいるはず」とのことです。サイバーナイフの治療は成功と言えるようです。
これで、しばらくは落ち着けるかと思いましたが、残念ながら左肺の一昨年末に手術したあたりに再発が見つかりました。昨年9月に撮ったCTを改めて見ると、このころから薄く見られるようになり、今回のCTでは、それがはっきりとして、かつ、大きくなっています。成長も速そうです。肺葉全体を取らなかったためでしょうか。
他の臓器に転移している可能性がありますので、PETを行うことになりました。ここで気になるのは、2019年7月13日に実施したPETで、がん細胞と思われるところも含めてどこも光らなかったことです。このとき、実は、PETを実施すると決まってからPETを実施するまでの2週間弱、毎日熱い風呂に10分間浸かるということを行っていました。それがPETが光らなかった原因かどうかを切り分けるため、今回も同じことをやってみることにしました。 |
||||||||||||||||||||||||||||||||
| 2021年2月16日(火) |
東邦大学医療センター大森病院にて、PETを実施しました。 |
||||||||||||||||||||||||||||||||
| 2021年2月19日(金) |
東邦大学医療センター大森病院にて、呼吸器内科を受診し、火曜日に実施したPETの結果を聞きました。 以下の3箇所が光りました。
右肺のサイバーナイフの治療痕は光りませんでしたので、やはり死んでいるようです。ただし、この腫瘍は、以前のPETでも光らなかったので、引き続き経過観察することになりました。 また、今回光ったのは3箇所ですが、PETでは小さい癌は光りませんし、リンパ節に転移していることから、他の臓器への転移もあることを前提として今後の治療方針を立てた方が良さそうです。1年間の被ばく線量は決まっていますので、もぐらたたきのように放射線治療を繰り返すのは得策ではありません。やはり、まずは、抗がん剤でたたけるだけたたくのが良いでしょう。そこで、CTガイド下生検で、左肺のリンパ節からがん細胞を採取して、遺伝子変異型を調べることとなりました。1泊2日の入院が必要ですので、3月2日に日程を決めることになりました。 なお、熱い風呂に毎日10分間浸かることが癌細胞の非活性化やPETで癌細胞が光らないことの原因ではなさそうです。前回のPETで、なぜどこも光らなかったのか、謎のままとなりました。 |
||||||||||||||||||||||||||||||||
| 2021年3月2日(火) |
東邦大学医療センター大森病院にて、呼吸器内科を受診し、CTガイド下生検の日程を以下のように決めました。
病棟は以前と同じ、3号館4階西。4人部屋です。 今回は、これまでの遺伝子検査に加えて、がん遺伝子パネル検査にも参加することとしました。これまでの遺伝子検査では、恐らく2019年12月の検査結果と変わらないのではないか、という予感がしたためです。 これまでの遺伝子検査と遺伝子パネル検査とを比較すると下表のようになります。遺伝子パネル検査は費用が8倍かかることと検査結果が出るまで2ヶ月もかかるところに難があります。また、検査結果で新たな遺伝子変異が見つかっても、適切な治療方法が無い可能性もあります。また、遺伝子パネル検査には「FoundationOne® CDx がんゲノムプロファイル」と「OncoGuide™ NCC オンコパネル システム」との2種類があります。調べる遺伝子の数の多いFoundationOne® CDx がんゲノムプロファイルを選択しました。(担当医もこちらを推奨しました)。
また、脳へ転移していないか、心配なので、4月8日に脳MRIを撮影することにしました。 |
||||||||||||||||||||||||||||||||
| 2021年3月22日(月) |
東邦大学医療センター大森病院から「明日10:30に2号館2階のMYステーションに来て、入院して下さい。」と電話がありました。 |
||||||||||||||||||||||||||||||||
| 2021年3月23日(火) |
東邦大学医療センター大森病院に入院しました。 コロナの影響で面会謝絶なので、一人で向かいます。 人手が足りていないのか、入院患者が多いのか、MYステーションは大混雑で、10:30に行っても、実際に入院手続きを行ったのは11:30でした。 前回と同じ、3号館4階西病棟内の4人部屋です。そして、前回と同じく窓際のベッドで、開放感があります。
12:20、普通に昼食を摂り、待機します。 15:00、声がかかり、歩いてCT室に向かいます。 CTガイド下生検は局所麻酔のため、意識のある状態で意思疎通をしながら行います。ただし、顔にシートを被せられるので、誰が何をどのようにやろうとしているかは分かりません。また、途中から発声はできなくなりますので、説明を一方的に聞かされるだけで、こちらからの意思表示は、手に持たされた非常用ブザーを通してでしかできません。 万歳の姿勢でCTの中に入り、最初に「普通の」呼吸で何枚か撮影します。がん細胞の位置を確認するためだそうです。そして、生体採取中も同じように「普通に」呼吸することを求められます。 どのくらい経ったでしょうか。いよいよ針を刺すことになりました。胸に圧迫感を感じます。 「だめだ、戻ってきちゃうんだよね」という声が聞こえます。もう一度、「いち、に、さん、」の掛け声で刺します。今度はうまく行ったようです。 「それでは、採取しますね」と声をかけられると、ほどなくパチンッという音がして、喉に空気がぶつかるような感じがしました。想像ですが、スポイトのように吸引したのではないかと思います。 「きちんと採取できているか確認しますので、少しお待ちください」と言われて、そのままの姿勢で待ちます。 「ちゃんと採れているようですので、これで終了です。」と言われ、CTの中から出されて、顔に被せられたシートが除去され、いろいろと外されます。時刻は16:30。少し難しかったようで、通常よりも長くかかったそうです。※通常、1時間あれば終わるそうです。 これから2時間、ベッド上で安静を求められますので、病室へはストレッチャーに乗せられて帰ります。 安静中は、トイレに行くことも許されないため、尿瓶で用をたします。 18:30、トイレに歩いて往復できることを確認し、安静解除です。 18:40、遅めの夕食を摂りました。 |
||||||||||||||||||||||||||||||||
| 2021年3月24日(水) |
8:30、朝食後、胸部レントゲン写真を撮りに行きした。 体調は良く、体温も血中酸素濃度も正常なので、看護婦さんは当然退院できるものと思い込み、「退院の準備をして、退院できるようになったら、ナースコールで呼んでくださいね」と言い残して、病室を出ていきました。 すると、ほどなくして、CTガイド下生検を担当した医師が慌ててやってきて、「肺がしぼんでいるので、今日退院はできません。」と言われました。いわゆる気胸です。 「自覚症状はないんですが、、、」 「レントゲン撮りに行ったとき、息苦しくなかったですか?」 「いえ、まったく。」 「そうですか、でも、退院させるわけには行かないんです。」 「明日になれば、退院できそうですか?」 「今、自覚症状が無い状態なので、このまま悪化しなければ、退院しても良いでしょう。逆に悪化すれば、追加措置が必要となりますので、いつ退院できるかは分からなくなります。」 「どうすれば、悪化は防げますか? 例えば、深呼吸するとか。」 「いいえ、気胸を早く治す方法は無いんです。とにかく、安静にしてください。」 このあと、この日退院できる想定で組んでいた翌日の予定を調整しなければなりませんでした。 |
||||||||||||||||||||||||||||||||
| 2021年3月25日(木) |
8:30、朝食後、胸部レントゲン写真を撮りに行きした。相変わらず、体調は良く、息苦しさはありません。悪化していないことを祈るばかりです。 CTガイド下生検を担当した医師がやってきました。 「良くはなっていないのですが、悪化もしていないので、退院しても良いでしょう。」 ほっと一安心です。 「万が一、息苦しいなどの症状が現れたら、救急外来ですぐに来院してください。それから、左手で重い荷物を持たないように注意してください。それ以外、日常生活は普通に過ごしていただいて結構ですが、激しい運動は禁止です。4月6日に生体検査の結果を聞くための呼吸器内科の診察が入っているようですので、この日にレントゲンも撮ってください。それで、肺が膨らんでいたらOKです。」 次回の日程が勝手に決められているなぁ、と思いましたが、4月の火曜日は念のため仮予定を入れてブロックしておいたので、そこは突っ込まないことにしました。 看護婦さんも、「今度は本当に退院できそうですね。」と嬉しそうです。 ただ、ここで一つ問題がありました。次回の診察日までタルセバが持たないので、約1週間分処方して欲しいと看護婦さんに頼んだところ、戻ってきて、次のように言われました。 「退院日までは、院外処方できないんです。そして、院内処方のタルセバは200mg錠しかなく、現在服用している100mg錠が無いんです。申し訳ないんですが、薬が切れる頃に、処方箋発行のために来院していただけませんか?」 システム上の問題か、なんらかの規制によるものなのか、不明でしたが、次週の火曜日に処方箋発行のために来院することとしました。 とにかく無事退院です。体調は入院前と変わりませんでしたが、念のため、タクシーで帰宅しました。 入院中の病院食を以下にすべて示します。
また、針をさした痕の時間経過も以下に示します。意外と消えません。
|
||||||||||||||||||||||||||||||||
| 2021年3月30日(火) |
東邦大学医療センター大森病院の呼吸器内科に、タルセバの院外処方せんを発行してもらうためだけに行きました。 |
||||||||||||||||||||||||||||||||
| 2021年4月6日(火) |
東邦大学医療センター大森病院の呼吸器内科を受診し、先日の生体検査の結果を聞きました。 予想通り、2019年12月の検査結果と変わり無く、新たな遺伝子変異は見つかりませんでした。
がん遺伝子パネル検査の結果が出るまで、もう1ヶ月半待つ必要があります。何もしないでただ待つよりはましだろう、ということで、アバスチンという血管新生阻害薬を投与することにしました。分子標的薬の一種で副作用が少なく、がん細胞の成長を遅らせる効果が期待されます。3週間~4週間に1回の頻度で、通院して点滴で投与します。投薬時間は、初回が90分、2回目は60分、3回目以降は30分です。4月13日(火)に最初の投薬を、5月11日(火)に2回目の投薬をすることにしました。 また、この日は気胸の状況を確認するために、胸部レントゲン写真を撮りました。気胸はすっかり治っていました。 |
||||||||||||||||||||||||||||||||
| 2021年4月8日(木) |
東邦大学医療センター大森病院にて、脳の造影MRI検査を行いました。 |
||||||||||||||||||||||||||||||||
| 2021年4月13日(火) |
東邦大学医療センター大森病院にて、呼吸器内科を受診し、その後、アバスチンを投与しました。 呼吸器内科の診察では、先生が「良いニュースと悪いニュースがあります」と切り出しました。 「まず、良いニュースですが、MRIでは異常な所見は見られず、脳には転移していないと考えられます。次に、悪いニュースですが、がん遺伝子パネル検査から『検体が足りない』と連絡がありました。」 「もう一度、CTガイド下生検をやるのですか?」 「いや、今回かなり難しかったらしく、『やり直して、十分な検体を採取できる自信が無い』と言っていますので、CTガイド下生検はやり直しません。あと2ヶ月ぐらいしたら、血液中のがん細胞を集める技術が使えるようになる見通しですので、それを待ちましょう。」 帰宅してインターネットで調べると、確かに「血中循環腫瘍細胞 濃縮回収装置」というものがあるようです。こうした装置が東邦大学医療センター大森病院に導入されるのでしょうか? ただ、こうした装置が使えるようになったとしても、そもそも、検体として供することができるほどのがん細胞が血液中にあるのか、そこが気になります。また、仮に、検体として十分な量のがん細胞が収集できたとしても、そこからがん遺伝子パネル検査を再開すると、結果が出てくるのは早くて8月頃になりそうです。 呼吸器内科の診察を終えると、アバスチンの投与を受けるため、外来化学療法室に移動しました。ここは、入院しなくても点滴による投薬を受けられるようにした、東邦大学医療センター大森病院独特の施設のようです。 受付後、一室に案内されました。入院病棟にあるベッドと同じベッドがカーテンで仕切られて並んでいます。受付時に渡された番号のベッドで投薬を受けます。今回は初回だったので案内してくれましたが、次回以降は、自分でベッドまで行かなくてはなりません。 受付をしてから薬剤の準備が始まるので、点滴が始まるまで30分間待ちました。薬剤によっては1時間ほど待つ場合もあるようです。点滴自体は、時間を決めて行うので、初回はぴったり90分で終わりました。副作用は元々少ないので、具合が悪くなることもありませんでした。 アバスチンは、副作用が少ないとはいえ、血圧が上昇し、高血圧になる可能性が高いそうです。血圧計を購入して、毎日測定し、手渡された『外来化学療法の症状日記』に記録して、次回持参することを勧められました。薬剤師は「高血圧になったからと言って投薬を中止するわけではなく、単に降圧剤を処方するだけなんですけどね。それに、来院時に病院でも測定しますから義務ではないんですけどね。」といささか申し訳無さそうでしたが、帰宅後、インターネットでシチズンの手首式の血圧計を購入しました。 |
||||||||||||||||||||||||||||||||
| 2021年4月20日(火) |
17日(土)頃から心臓のやや下の高さの左脇腹に張りを感じるようになり、ときどき息が詰まるような鈍痛に見舞われるようになりました。 我慢できない痛みではないのですが、気になるので、東邦大学医療センター大森病院に行って、とりあえず呼吸器内科を受診しました。 肋間神経痛という診断で痛み止めが処方されましたが、以前手術後に経験した肋間神経痛とは場所も痛みの出方も異なるので、恐らく誤診だろうと思い、薬は飲まず、様子を見ることにしました。 すると、痛みは徐々に軽くなり、翌日の水曜日中に消えて無くなりました。 |
||||||||||||||||||||||||||||||||
| 2021年4月23日(金) |
明け方3時頃、左下腹部に攣るような痛みを感じ、目を覚ましました。我慢できる程度の痛みだったので、しばらく我慢していると、10分ほどで痛みが無くなったので、また眠りに落ちました。 翌朝、尿をすると、血尿が出てきました。
アバスチンの説明書には、副作用として、血痰、血便は記載されていますが、血尿はありません。恐らく副作用ではないだろうと判断し、東邦大学医療センター大森病院に行き、呼吸器内科と泌尿器科を受診したいと申請しました。 呼吸器内科の先生の診断は「アバスチンの副作用」で、止血剤が処方されました。でも、恐らくこの診断は誤診であろうと思い、念のため、泌尿器科も受けさせてもらうこととし、院内の紹介状を書いてもらいました。 泌尿器科では、まず尿検査とCT検査を行いました。CTでは、球状のものが写っています。尿管結石です。がんは関係ないのでしょうか? CTを見る限り、腎臓や膀胱に転移は見られません。でも、念のため、尿の中にがん細胞がないか、検査して頂くことになりました。 尿管結石は女性の出産に次ぐ激痛に見舞われると言われますが、私の場合、まったく痛みがありません。泌尿器科の医師に言わせると、「それはたまたま」で、「このあと吐きそうになるくらいの激痛に見舞われる可能性がある」とのことで、座薬を10錠処方されました。また、「早く出すためには水を大量に飲んだ方が良い」と言われますが、この医師によれば「そのエビデンスは無い」とのことで、出しやすくする薬としてウロカルン錠が処方されました。 今回の件で学んだことは、自分の体のことは自分で判断すべき、ということです。インターネットで「脇腹痛」で検索すると、その原因として、尿管結石は候補に上がります。何科の医師であれ、それぞれの原因を一つ一つ確認し、絞り込んで、検査をして、確定する、というプロセスを踏んでもらいたいものです。しかし、現代医療では分業体制がはっきりしすぎていて、呼吸器内科の先生は、呼吸器起因の原因しか検討しないようです。これに対処するためには、自分で絞り込みを行い、病院を検査施設して使って、自ら原因を確定していく必要がありそうです。 ちなみに、このあと、27日、29日、30日、5月3日に、我慢できないほどの痛みに襲われ、座薬を使いました。 |
||||||||||||||||||||||||||||||||
| 2021年5月6日(木) |
11:45 尿をすると、写真のように便器の底に黒い塊があることに気づきました。 排尿中、尿道に違和感や痛みを感じることはありませんでした。また、色が黒いです。※このときは、結石の色は白だと思いこんでいました。 拾う勇気が無く、写真を撮ったあと流してしまいました。
その後、痛みが出なかったので、恐らくこれが結石が出た瞬間だったのだと思われます。血尿が出てから13日間かかりました。 |
||||||||||||||||||||||||||||||||
| 2021年5月11日(火) |
東邦大学医療センター大森病院にて、呼吸器内科を受診し、その後、アバスチンを投与しました。 アバスチンの投与時間は、アレルギー性のショック症状が出ないかどうかを確認しながら、だんだん短くしていきます。90分、60分、30分という感じです。今回は2回目なので60分です。 点滴の針を刺すときに、看護婦さんから「今度からここに来る前に水を500mlぐらい飲んできてくださいね。血管が太くなって針が指しやすくなるので」と言われました。 よほど難しかったのか、今回は、下図のように、皮下漏洩してしまいました。
|
||||||||||||||||||||||||||||||||
| 2021年5月28日(金) |
東邦大学医療センター大森病院にて、まず胸部CTを撮りました。 その後、泌尿器科でもCTを撮るであろうと予想したので、まず泌尿器科の受付に行って、「これから胸のCTを撮りに行って、そのあとここを受診するのですが、恐らく、ここでもCTを撮ることになるので、これから撮るCTで、胸だけじゃなくて下腹部まで撮るように指示してもらえませんか」と言いましたが、「誰が診るか分からないので」とけんもほろろに断られました。 仕方なく、まず胸だけのCTを撮って、泌尿器科を受診しました。 確かに、先生は前回と異なり、女性の先生でした。 5月11日に出たと思われ、その後痛みが出ていないことを、写真を見せながら説明しました。 「ただ、色が黒いんですよね。白いと思うんですが、、、」 「いえ、黒とか茶色とかが多いですよ。」 「まわりに血が付くからですか?」 「いえ、石自体が黒とか茶色なんです。拾ってないんですよね。写真だけだと判断できないので、念のためCTを撮りましょう。」 ということで、予想通り、もう一度CTを撮りました。累積放射線量という観点でもこういうことは避けたいところですね。 もう一度、CTの画像を見ながら診察です。尿管のところには石らしいものは見られません。その代わり、別のところに強く光る点が写っています。 「これは何ですか?」 「これは、腸管の部分なので、食べ物か何かだと思いますよ。」 何となくそうではない気がしましたが、後日呼吸器内科の先生にも聞いてみよう、と考え、それ以上つっこみませんでした。 「そうそう、尿にがん細胞が出てないか試験して、その結果が出ていますね。CLASS IIですので正常です。CLASS IIまでが正常なんです。がん細胞はいませんね。」 一安心です。 |
||||||||||||||||||||||||||||||||
| 2021年6月8日(火) |
東邦大学医療センター大森病院にて、血液検査と尿検査を実施し、呼吸器内科の診察を受けて、外来化学療法室でアバスチンの投与を受けました。 血液検査、尿検査ともに異常無しです。 5月28日に撮ったCTも異常無しです。むしろ、改善が見られました。 右肺の腫瘍は、放射線治療後も色が薄くなったとはいえ、影が写っていました。医師からは「おそらく、死んでいるか、非活性化していると思いますが、念のため、大きくならないか観察していきましょう」と言われていましたが、それがすっかり消えて無くなっています。※5月28日の画像の広く大きい白い影は放射線による「やけど」の痕で、がん細胞ではありません。
左肺の腫瘍も、若干小さくなっているように見えます。
医師は「進行していなければ良いので、良い状態です」と満足そうです。 最近治療として行っているのは、以下の3つだけです。
再発したことを考えると、タルセバはもはや効いていないと考えられます。アバスチンも血管新生阻害薬として癌の増殖や転移を防ぐ効果は期待されますが、がん細胞を殺す効果は期待できません。そうなると、温熱療法の効果としか考えられません。温熱療法は意外と辛いので「今回のCTで変化が見られなければやめよう」と考えていましたが、やめずに継続することにしました。 5月28日のCTで腸管に見られた強く光る点についても聞いてみました。 「尿管結石が無いか診るために撮った下腹部のCTで、腸管の辺りに光る点が写っていたんです。泌尿器科の先生は『食べ物だろう』って言うのですが、念のため見ていただけませんか?」 泌尿器科で撮ったCTを画面に写して、見てくださいました。 「これは血管の石灰化ですね。老化現象ですね。動脈硬化の一種です。癌ではありませんよ。」 「癌ではありませんよ」に安心し、「老化現象ですね」に傷つきました。 呼吸器内科の診察のあと、アバスチンの投与を受けました。本来は、3回目なので30分で投与するはずですが、なぜか呼吸器内科の先生の指示は60分になっていました。外来化学療法室の看護婦さんが呼吸器内科の先生に確認を取ろうとしてくれましたが、「救急の対応中でつかまらない」とのことで、指示通り60分で投与しました。 アバスチンの副作用である高血圧を監視するために、毎日血圧を測り『外来化学療法の症状日記』に記録して、毎回、外来化学療法室の看護婦さんと薬剤師さんに確認してもらっています。それをグラフ化したのが下図です。※この日の時点では、まだ、高血圧の症状は見られませんでした。
|
||||||||||||||||||||||||||||||||
| 2021年6月11日(木) |
都合により出勤しました。 15:00頃トイレにいて、鏡を覗くと左目の白目が赤いです。よく見ると出血しています。ぶつけたり、目を強くこすったりした記憶はありません。
インターネットで調べてみると結膜下出血というもので、治療の必要は無いようなので、放置することにしました。それにしても、つくづくポンコツな体だなぁ、と感じます。 その後の経過を経過日数とともに示します。
|
||||||||||||||||||||||||||||||||
| 2021年7月6日(火) |
東邦大学医療センター大森病院にて、血液検査と尿検査を実施し、呼吸器内科の診察を受けて、外来化学療法室でアバスチンの投与を受けました。 血液検査、尿検査ともに異常無しです。 7月13日(火)にモデルナ製のコロナウィルスワクチンを接種する予約を入れているので、念のため、呼吸器内科の先生に問題ないか問い合わせましたが、問題ないとのことでした。 |
||||||||||||||||||||||||||||||||
| 2021年7月13日(火) |
コロナウィルスワクチン(モデルナ製)職域接種(第1回) |
||||||||||||||||||||||||||||||||
| 2021年8月5日(木) |
東邦大学医療センター大森病院にて、血液検査と尿検査を実施し、呼吸器内科の診察を受けて、外来化学療法室でアバスチンの投与を受けました。 呼吸器内科の診察で先生が「良い話と悪い話があります。」と始めました。続けて 「まず、悪い話ですが、血液検査で腫瘍マーカーCEAの値が急に上がったんですよ。」 確かに、前回の4.8から7.3に急増しています。CEAは肺がんが最初に見つかった頃から観察している腫瘍マーカーですが、がんが明らかにある時でもずっと低いままでした。それが昨年7月ごろから徐々に上がり始め、今回急増しました。このため8月24日に胸部CTを撮ることになりましたが、大腸など消化器系のがんの発症の可能性も考えておいた方が良いかもしれません。 「次に、良い話ですが、FoundationOne®が保険の対象になりました。」 「でも、がん細胞が採取できないと、遺伝子検査にかけられないと思うのですが、血液からがん細胞を採取する技術は認可されたのですか?」 「それも認可されたので、CTと同じ日に血液採取もやりましょう。もしかしたら、もう一度、FoundationOne®の書類に署名しもらう必要があるかもしれません。それは、次回の診察までに確認しておきますね。」 正直、血液から遺伝子検査に十分ながん細胞のDNAが採取できるのか、まだ懐疑的なのですが、信頼性のない技術を認可しないと思うので、喜びたいと思います。 「ただし、前にも申し上げましたが、遺伝子検査の結果が出るまで2ヶ月ほどかかりますので、ご了承ください。」 これは致し方ありません。 |
||||||||||||||||||||||||||||||||
| 2021年8月10日(火) |
コロナウィルスワクチン(モデルナ製)職域接種(第2回) この日の夜から38度の発熱が1日間続きました。 |
||||||||||||||||||||||||||||||||
| 2021年8月24日(火) |
東邦大学医療センター大森病院にて、FoundationOne®のための採血と胸部CT撮影を行いました。 採血は、時間をかけて大量に採血するのかと思いましたが、わずか試験管2本でした。 本当に、採取した血液の中に癌細胞が必ずいると言えるほどの密度で癌細胞が循環しているのだろうか、それを調べていて、大きな勘違いをしていることに気づきました。 循環しているのは、癌細胞ではなく、癌細胞由来のDNAまたはその断片のようで、遺伝子プロファイル検査は、これを元に行っているようです。 これならば、納得です。そして、長年の疑問だった、肺癌が脳血管関門を通り抜けて脳に転移する仕組みにもこれが関係しているような気がしてきました。※肺がんではありませんが、乳がんの脳転移に関して『乳がんの脳転移メカニズムにエクソソームが関与 脳転移の早期診断への応用に期待』というプレスリリース(2015年)がありました。 |
||||||||||||||||||||||||||||||||
| 2021年9月7日(火) |
東邦大学医療センター大森病院にて、血液検査と尿検査を実施し、呼吸器内科の診察を受けて、外来化学療法室でアバスチンの投与を受けました。 診察では、まず、この日の血液検査の結果を聞きました。前回(8月5日)に7.3まで急増したCEAの値は、今回8.6と、さらに上昇しました。 「大腸とか、消化器系の新規の癌が発生した可能性はないのでしょうか?」 「2月に実施したPETの結果を踏まえると、多発性癌は考えにくいですね。おそらく、リンパ節に癌が転移し、増えていることが原因ではないかと思います。」 先生も、CEAが増えている原因に関しては、よく分かっていないようです。 次に、8月24日に撮影した胸部CTの結果を一緒に見ました。右肺の腫瘍に関しては、放射線による治療痕がほぼすべて消失していました。左肺の腫瘍に関しては、変化無しです。大きくも小さくもなっていません。すぐ近くのリンパ節も同様です。 ただ、左鎖骨上のリンパ節だけは、肌の上から触れて分かるほど大きくなっています。先生にも触診してもらい、「なぜ、こんな違いが出るのでしょうか?」と尋ねましたが、首をかしげるだけで、「それよりも、」と話をそらされてしまいました。 「それよりも、FoundationOne®の解析結果の仮レポートが出てきているんですよ。」 「もう出たんですか?!」 「こんなに早く出るとは思わなかったのですが、、、」 「それで、新しい遺伝子変異は見つかりましたか?」 先生と一緒に英語のレポートをパソコンの画面で確認していきます。残念ながら、exon 19 deletionというこれまで見つかった遺伝子変異以外は見つかりませんでした。そして、推奨薬も、以下の通り、代わり映えしません。※アルファベット順
これでは、なぜイレッサやタルセバが効かなくなったのかは不明のままですし、他の推奨薬にスイッチしたところで効果は期待できません。 一応、本レポートが出てきたら、エキスパートパネルで慶応大学の先生と相談していただき、次の治療方針を決めていただくことになりましたが、先生の予想としては、いわゆる普通の抗がん剤を使うことになるのでは、とのことでした。 アバスチンを投与するようになってから、舌の表面が荒れ、舌先に小さな斑点がリング状に現れ、ヒリヒリするようになりました(下図)。
アバスチンの投与の前に、巡回してくる薬剤師に、舌の先を見せながら、「アバスチンの副作用でしょうか?」と尋ねましたが、「さぁ、聞いたことないですね。」とつれない返事でした。 |
||||||||||||||||||||||||||||||||
| 2021年10月5日(火) |
東邦大学医療センター大森病院にて、血液検査と尿検査を実施し、呼吸器内科の診察を受けて、外来化学療法室でアバスチンの投与を受けました。 血液検査では、CEAが9.6に上昇しました。腫瘍マーカーの値をグラフ化すると、7月以降、デジタルに変化しているので、体の変化というよりは、施策の変化の結果のように思われます。施策として最近大きく変えたのは、4月以降、月1回アバスチンを投与していることです。そこで、先生に「アバスチンの影響とは考えられませんか?」と聞いてみましたが、「それは無い」と即答されました。 FoundationOne®のエキスパートパネルは、この日に開催されるとのことで、残念ながら、新しい治療方針は示されませんでした。 FoundationOne®でも、新しい遺伝子変異は見つからず、イレッサやタルセバへの耐性に関わる変異が分かりませんでしたので、 「FoundationOne®で検出できない変異が耐性に影響を与えていると言うことでしょうか?」と聞くと、 「現代の最先端の医学でも分からないということです。そもそもイレッサを7年間も投与し続けるということが稀で、なぜそうなったのかが分かりません。なので、なぜ耐性が生まれたのかも分かりません。」とのお答えでした。 それほど稀な現象なら、なぜ私を研究対象としたいと思わないのでしょうか。今の先生だろうが、他の大学の先生だろうが、そのようなお申し出があれば、喜んで協力するのに、、、 例えば、私が癌の研究者だったら、癌細胞の遺伝子変異を調べるのではなく、患者のDNAの方を解析するでしょう。私のDNAと、イレッサに対する耐性が1年程度で現れた一般的な患者さん(多数)のDNAとを比較して、私のみが持っている塩基列を抽出すれば、それがイレッサの耐性に関わる塩基列であると推察できるはずです。 結局、もう1ヶ月、アバスチンの投与とタルセバの服用を継続することになりました。 左鎖骨上のリンパ節は少し小さくなりましたので、慌てて対策を取る必要はなさそうです。先生に触診していただいて確認していただきました。押しても痛くないので、風邪などの炎症によるリンパ節の腫れではなく、癌細胞の増殖による肥大であると考えるのが妥当で、それが小康状態になっていると考えられるそうです。なぜ、ここだけが一時的に肥大し、また少し小さくなったのか、先生には「分からない」とのことです。 でも、私には心当たりがありました。実は、前回の診察のあと、それまで鎖骨を出して風呂に浸かっていたのを、首まで浸かるように変更していたのです。このことから、どうやら私には42度ぐらいの熱いお湯に浸かる温熱療法は効きそうであること、そして、半身浴ではだめで、患部を外から暖めるようにしなければならないこと、が分かりました。 |
||||||||||||||||||||||||||||||||
| 2021年10月21日(木) |
まごめクリニックにて、風しんの抗体検査を受診しました。 |
||||||||||||||||||||||||||||||||
| 2021年10月26日(火) |
まごめクリニックに電話をして、風しんの抗体検査の結果速報を聞きました。 残念ながら、抗体価は8未満で、予防接種が必要です。 「インフルエンザの予防接種を受ける場合は、先にインフルエンザの予防接種をして、それから7日以上開けて、風しんの予防接種をするように」と言われました。 |
||||||||||||||||||||||||||||||||
| 2021年11月2日(火) |
東邦大学医療センター大森病院にて、血液検査と尿検査を実施し、呼吸器内科の診察を受けました。 この日の血液検査でも、CEAが9.8に若干上昇しました。 FoundationOne®のエキスパートパネル(慶応大学の先生)のご意見は、「現在行っているタルセバの服用とアバスチンの投与の代わりに、タグリッソの服用を試す」というものでした。 タグリッソは、イレッサやタルセバと同じEGFR阻害薬の「第3世代」で、特にT790Mという変異が追加で発現した場合に効果があるとされていますが、私にはこの変異は発現していませんので、どれだけ効くかは未知数です。 副作用は、イレッサやタルセバとほぼ同じです。(発生率は異なります) 課題は、価格が高いことです。1錠21,000円で、保険が適用されても患者負担は7,000円になります。毎日服用すれば、30日で210,000円です。「高額療養費の申請を忘れないでください」と言われました。 他に良さそうな選択肢はありませんので、試してみることにしました。価格並みの効果がみられますように、祈るばかりです。 そして、2週間後に副作用の確認をすることにしました。 それから、この数日前から時々空咳が出るようになったので、診てもらいました。 肺は正常で、喉が少しだけ赤くなっているとのことで、消炎剤と咳止めが処方されました。 また、インフルエンザの予防接種を受けました。コロナウィルスでワクチンの効果を目の当たりにした人が増えたせいか、インフルエンザのワクチンの接種希望者が多く、ワクチンが不足しているそうです。大学病院で接種する人が少ないため、大学病院では余っているようで、先生から「接種するならこの病院でしていくことを勧めます」と言われました。 |
||||||||||||||||||||||||||||||||
| 2021年11月16日(火) |
東邦大学医療センター大森病院にて、血液検査と尿検査、胸部X線撮影を実施し、呼吸器内科の診察を受けました。 タグリッソの副作用の有無は下記の通りです。
タルセバで見られた鼻の頭や口の周りの発疹やニキビはきれいに無くなりました。
その代わり、血小板が減少する副作用の影響で、鼻血が出るようになりました。鼻をかんだだけで両鼻から血が出たり(下図)、ふとした拍子にタラーッと鼻血がたれてくることもあります。
9月7日のところに「アバスチンの副作用ではないか」と書いた舌の先の発疹も、タルセバの服用とアバスチンの投与をやめたらなくなりました。ですので、どちらかの副作用であったことは間違いないと思われます。 タグリッソに関し特に重篤な副作用は出ていないので、このまま継続することとなりました。 なお、左鎖骨上のリンパ節はだいぶ小さくなり、触っても、左右差が分からないほどになりました。これは、タグリッソの効果と言うには早すぎますので、やはり、温熱療法の効果と言えそうです。 それから、空咳が相変わらず出ます。長い間話す際には、龍角散のど飴が手放せなくなりました。お薬をアスベリン錠に変えてもらいました。 |
||||||||||||||||||||||||||||||||
| 2021年11月27日(土) |
10年ぶりぐらいにグレープフルーツジュースを飲みました。 タグリッソの説明書には、これまでのイレッサやタルセバの説明書に見られた「グレープフルーツを食べてはいけません」という注意書きが見られません。そこで、11月16日にタグリッソを受け取るときに、薬剤師の方に確認してみたところ、「きちんと検証されているので大丈夫ですよ」とのことです。 グレープフルーツが特段好きというわけではありませんが、これまで食べてはいけないと言われていたものが食べられるとなると、食べたくなるものです。そこで、近所のスーパーマーケットでグレープフルーツを探しましたが、最近不人気らしく、売られていません。仕方なく、グレープフルーツジュースを買いました。 このあと、2週間くらい飲み続けてみましたが、特に、副作用が重症になるような傾向は見られませんでした。 |
||||||||||||||||||||||||||||||||
| 2021年12月12日(日) |
何もしていないのに、突然左腹の腹筋が攣りました。このあと、時々発生するようになりました。ただ、写真のように外観には特に異常は見られません。
|
||||||||||||||||||||||||||||||||
| 2021年12月16日(木) |
まごめクリニックにて、風しんの予防接種を行いました。 |
||||||||||||||||||||||||||||||||
| 2021年12月22日(水) |
何もしていないのに、右手の中指、薬指、小指が攣りました。最近、これまで攣ったことがないところが攣るようになりました。 |
||||||||||||||||||||||||||||||||
| 2021年12月23日(木) |
出勤しました。 環境の変化のせいか、急性アレルギー鼻炎のように、鼻水とくしゃみが止まらなくなり、難儀しました。 |
||||||||||||||||||||||||||||||||
| 2021年12月25日(土) |
外出して、夜帰宅時に腰痛になりました。 これまでの経験から、これは運動不足によるもので、翌日から最低30分は散歩をするようにしたところ、3日で治りました。 |
||||||||||||||||||||||||||||||||
| 2021年12月28日(火) |
12月25日(土)頃から喉が痛くなり、27日(月)~28日(火)に37.2度の微熱が出ました。 病院も年末年始の休暇に入るので、念のため、近くの藤井内科クリニックで発熱外来を受けることにしました。 発熱外来は、37.5度以上の発熱のある人を対象にしたものですが、万が一コロナに罹患していることを想定して、事前に藤井内科クリニックに電話をして予約をしました。 「5時に来院して、病院には入らず、外から電話してください。」と言われたので、そうすると、看護婦さんが迎えに来て、裏口から病院に入ります。 特別に用意された病室で、鼻水を採取し、新型コロナ抗原検査とインフルエンザ抗原検査を行います。15分後に結果が出て、医師の診察を受けます。 「どちらも陰性です。喉を見ると扁桃腺炎ですね。薬で治しましょう。」 アモキシシリンが1週間分処方されました。 このとき、下痢止めも一緒に処方されたので、合わせて服用したところ、服用している期間のみ、見事に下痢が止まりました。 |
||||||||||||||||||||||||||||||||
| 2022年1月4日(火) |
喉の痛みが一向に改善せず、食事をするのも難儀なため、この日から営業している西馬込あくつ耳鼻咽喉科で診てもらいました。 鼻から入れたカメラの画像を見ながら「喉に口内炎が幾つかできていますね。お薬変えさせていただきますね。それから、鼻血が出にくくなるように軟膏も処方しておきますので、両鼻の穴によく塗ってください。」と言われました。 処方された抗生剤はラスビック錠75mg(5日分)でした。 |
||||||||||||||||||||||||||||||||
| 2022年1月5日(水) |
この日は、体の不調が複数発生しました。
|
||||||||||||||||||||||||||||||||
| 2022年1月6日(木) |
東邦大学医療センター大森病院にて、血液検査、尿検査を実施し、胸部CTを撮りました。 この日は東京でも昼前から雪が降り始めていたので、積もって歩けなくなる前に急いで帰宅しました。写真は、帰宅途中の池上本門寺多宝塔の様子です。
|
||||||||||||||||||||||||||||||||
| 2022年1月7日(金) |
約10年ぶりにグレープフルーツを食べました。 売っているところが少なく、人気が無くなっていることに驚きました。
|
||||||||||||||||||||||||||||||||
| 2022年1月11日(火) |
東邦大学医療センター大森病院にて、呼吸器内科の診察を受け、6日に実施した血液検査、尿検査、胸部CTの結果を聞きました。 血液検査、尿検査ともに異常無しでした。それどころか、一時9.8まで上昇していた腫瘍マーカーCEAの値が一気に1.4まで下がりました。先生はタグリッソの効果だとおっしゃっていますが、私は、後述の通り、肺に再発した腫瘍の大きさがタグリッソを服用してから変わっていないことから、アバスチンの副作用だったのではないかと推察しています。ただ、腫瘍は小さくなっていませんが、大きくもなっていませんので、タグリッソが全く効いていないとは言えないため、もう2ヶ月服用して様子を見ることにしました。 また、喉の口内炎は、やはりタグリッソの副作用と考えられるそうです。ただ、だいぶ痛みは収まっているので、先生は、この副作用のためにタグリッソをやめるという判断はされませんでした。「その代わり、できるだけ口の中を清潔に保つように」とおっしゃいました。 胸部CTでは、左肺の腫瘍の大きさは、タグリッソ服用前と変わっていません。大きくも小さくもなっていません。タグリッソは増殖を抑えるだけなので、効いていないとは言えませんが、値段ほどの仕事はしてくれていないように感じます。
ここで、最近体を反らすと背骨が痛いことを相談しました。骨への転移が疑われますが、CTで見る限り、骨破壊のような症状は見られません。念のため、全身のPETを実施することにしました。 |
||||||||||||||||||||||||||||||||
| 2022年1月15日(土) |
喉の口内炎を治療して下さった西馬込あくつ耳鼻咽喉科の先生が「ビタミンCを摂ると良いですよ」とおっしゃっていたので、再発防止のために、ビタミン剤を摂ることにしました。
口内炎と同様に、他の分子標的薬よりもひどくなった副作用として「爪がもろくなる」があります。両手のすべての爪が弱くなり、割れたり、裂けたりして、ボロボロです。
|
||||||||||||||||||||||||||||||||
| 2022年1月16日(日) |
もう一つ、下痢も他の分子標的薬よりもひどくなった副作用の一つですが、不思議なことに、この日から圧倒的に少なくなりました。下図のように、排便の数は変わらずに、下痢の回数だけが少なくなっています。
|
||||||||||||||||||||||||||||||||
| 2022年1月20日(木) |
この頃から、いろいろな症状が見られ、その度に、癌が転移したのかな、あるいは、タグリッソの副作用なのかな、と神経質になってしまいます。 この日は、なぜか、左手の指が攣ってキーボードが打てなくなることが度々起こりました。
|
||||||||||||||||||||||||||||||||
| 2022年2月1日(火) |
歩くと、なぜか、左足裏の中央が足底腱膜炎になったように痛いです。 足裏を触ると、痛みのあるところに、小さな豆粒のようなしこりを感じます。 このしこりは、日々成長して、2日後には、肉眼で分かるようになりました。下図の黄色い丸の下3分の1のあたりに、赤い色に囲まれた少し青みがかった部分がありますが、それがしこりです。
※このしこりは約3ヶ月で消失しました。 |
||||||||||||||||||||||||||||||||
| 2022年2月18日(金) |
副作用の下痢が無くなってから1ヶ月経った頃から、鼻をかんでも鼻血が出なくなりました。 また一つ副作用が消えました。早くもタグリッソが効かなくなったのでしょうか? |
||||||||||||||||||||||||||||||||
| 2022年2月26日(土) |
東邦大学医療センター大森病院にて、PETを実施しました。 |
||||||||||||||||||||||||||||||||
| 2022年2月27日(日) |
口の中の左側奥が痛くなりました。鏡で見ても特におかしなようには見えませんが、押すと痛いです。口内炎ではなく、原因不明です。 ※この口の中の痛みは約2週間で無くなりました。 |
||||||||||||||||||||||||||||||||
| 2022年3月8日(火) |
東邦大学医療センター大森病院にて、血液検査、尿検査、呼吸器内科の診察を受け、2月26日に実施したPETの結果を聞きました。 血液検査・尿検査は異常無しです。 腫瘍マーカーCEAの値は1.2(正常)です。先生は相変わらずタグリッソの効果と考えています。私が改めて「アバスチンの副作用だったのではないでしょうか?」とたずねましたが、「分かりませんね」との回答でした。
「1月中旬ごろから下痢が圧倒的に少なくなって、2月中旬ごろから鼻血が出なくなったんです。副作用が無くなると、薬が効いているのか、不安になります。」と言うと、先生は 「副作用が無くなると心配するのは世界で日本人だけだそうですよ。アメリカでは、副作用が無い治療の方が好まれるようですから」 いや、それは日本人も同じでしょ。はじめ出ていた副作用が無くなることと、はじめから副作用が無いことを同列に議論はできないでしょ。と思いましたが、時間の無駄になりそうなので、 「へぇ、そうなんですね。面白いですね。」と流してしまいました。 PETの結果は良好でした。 光ったのは左肺の腫瘍だけです。左肺のリンパ節、左鎖骨下のリンパ節の転移は消えて無くなりました。他の臓器への転移も見られません。 ただ、左肺の腫瘍は、大きくなっていませんが、小さくもなっていません。そこで、「サイバーナイフで、とりあえず癌の無い状態にしてしまいましょう」ということになりました。サイバーナイフは、以前と同じ横浜市東部病院で行います。また、紹介状を書いてもらうことになりました。 |
||||||||||||||||||||||||||||||||
| 2022年3月10日(木) |
新型コロナウイルスのワクチン(モデルナ製)の3回目接種をキヤノン株式会社下丸子体育館で受けました。 その夜から24時間、38度の熱が出ました。
|
||||||||||||||||||||||||||||||||
| 2022年3月16日(水) |
この日から、下痢の回数が元に戻りました。原因不明です。 |
||||||||||||||||||||||||||||||||
| 2022年3月19日(土) |
2月27日に痛くなった口の中の左側奥に、今度は水疱のようなものができました。痛くは無いのですが、場所が同じなので、気になります。
|
||||||||||||||||||||||||||||||||
| 2022年3月25日(金) |
横浜市東部病院に、サイバーナイフの予約をしに行きました。 今回は、呼吸器内科の診察は無しで、いきなり放射線科の診察を受け、日程調整を行います。 前回は3回の照射で済みましたが、今回は腫瘍のすぐ近くに太い血管が通っているとのことで、少し弱い放射線を5回に分けて照射することになりました。これは、なるべく連続して5日間通院できるようにスケジュールしなければならないことを意味します。はじめ4月の中旬を打診されましたが、仕事が既に埋まっていて実施するのは難しそうです。結局、5月の中旬に実施することにしました。 「金マーカーは以前のものが使えるのですか?」 「いえ、新たに埋めなくてはいけないんです。しかも、今回は、すぐに脱落してしまいそうなところに置かないと行けないので、できる限り直前に置きたいのです。」 「じゃぁ、その日程も決めなくてはいけないんですね?」 「そうなんです。でも、今回は、肺のかなり上部にあるので、呼吸であまり動かない可能性があります。その場合は金マーカーは要りません。」 「金マーカーが要るか要らないかは、どうやって判断するのですか?」 「CTで分かります。」 「それはいつやるんですか?」 「それもスケジュールしないと行けないですね。」 なんか頼りないなぁ、、、と思いつつ「それもなるべく直前にやる必要があるのですか?」 「いえ、それはいつでも大丈夫です。」 「それならば、今日できますか? 今日やって、金マーカーが要るかどうかを明らかにしてから、日程を立てた方が良くありませんか?」 というスットコドッコイな会話をして、この日にCTで金マーカーが要るかどうかを判断してもらいました。 結果は、金マーカーは要らないとのことで、金マーカーを置く簡易手術は不要となりました。 |
||||||||||||||||||||||||||||||||
| 2022年4月9日(土) |
なぜか、右足内側の膝のすぐ下あたりの骨が痛くなりました。ぶつけた記憶はありませんし、外見は、左足と変わらないように見えます。
※この痛みは約2週間で消えました。 |
||||||||||||||||||||||||||||||||
| 2022年5月10日(火) |
東邦大学医療センター大森病院にて、呼吸器内科の診察を受けました。 当初は、サイバーナイフが終わって、その状況報告をする予定でしたが、まだ実施していないので、「何か気になることはありませんか?」と聞かれました。 2022年1月11日にも相談したのですが、相変わらず、CT撮影などで仰向けに寝た状態で足を上げると胃の後ろあたりの背骨が痛いので、それが気になると言いました。 すると、今度は、「MRIを撮りましょう」ということになり、6月14日にMRIを撮影することになりました。 タグリッソを処方してもらって帰りました。 |
||||||||||||||||||||||||||||||||
| 2022年5月16日(月) |
済生会横浜市東部病院で、サイバーナイフ治療1回目です。 前回と違ったことが2つありました。一つは治療室の気温です。前回はとても寒く、途中でトイレに行きたくなって、中断してもらったのですが、今回はそれほど寒くありませんでした。私と同じように中断する人が多かったのでしょうか? それでも、念のため、毛布を1枚余計にかけてもらいました。 もう一つは音楽です。患者をリラックスさせるために音楽をかけながら治療を行うのですが、前回はクラシックがかかっていたのに、今回は、なぜか安全地帯でした。私の年齢からの選択なのか、安全地帯の音楽にリラックス効果があることが認められたのか、選択の理由が気になりました。 少しウトウトしかけたところで終わりました。 この日に、サイバーナイフ治療費全額を支払いました。 |
||||||||||||||||||||||||||||||||
| 2022年5月17日(火) |
済生会横浜市東部病院で、サイバーナイフ治療2回目です。 |
||||||||||||||||||||||||||||||||
| 2022年5月19日(木) |
済生会横浜市東部病院で、サイバーナイフ治療3回目です。 |
||||||||||||||||||||||||||||||||
| 2022年5月20日(金) |
済生会横浜市東部病院で、サイバーナイフ治療4回目です。 |
||||||||||||||||||||||||||||||||
| 2022年5月23日(月) |
済生会横浜市東部病院で、サイバーナイフ治療5回目です。 最終回なので、放射線科の診察があり、無事予定の照射を終えたとの報告を受けました。同じ報告が東邦大学医療センター大森病院にもされるとのことです。 診察分の診療費を支払い、医療保険申請用の診断書作成を依頼して、帰りました。 |
||||||||||||||||||||||||||||||||
| 2022年6月14日(火) |
東邦大学医療センター大森病院にて、腰の上の方の背骨のMRIを撮りました。 |
||||||||||||||||||||||||||||||||
| 2022年6月21日(火) |
東邦大学医療センター大森病院にて、血液検査、尿検査、呼吸器内科の診察を受け、6月14日に実施したMRIの結果を聞きました。 結果は「分かりません」。どうやら、指示ミスで、腰の上のあたりではなく、胸部のMRIを撮ったようでした。 しかも、「私の専門外なので、整形外科に診てもらいましょう」と言い始めたので、急遽整形外科を受診することになりました。 整形外科を受診すると、まず背骨のレントゲンを撮りました。異常は見られません。でも、「MRIでしか分からないこともある」とのことですので、やはりMRIを撮ることになりました。東邦大学医療センター大森病院のMRIは1ヶ月待ちとのことで、6月23日に近くの提携病院である牧田総合病院で撮り、画像をCDに焼いてもらって、28日にそれを一緒に見ながら診断することになりました。 |
||||||||||||||||||||||||||||||||
| 2022年6月23日(木) |
牧田総合病院でMRIを撮り、画像をCDに焼いてもらって、持ち帰りました。 最近建て替えたのか、とてもきれいな病院でした。 |
||||||||||||||||||||||||||||||||
| 2022年6月28日(火) |
東邦大学医療センター大森病院にて、整形外科の診察を受けました。 牧田総合病院で焼いてもらったCDを東邦大学で取り込み、東邦大学の先生と一緒に結果を見ました。 幸い、骨への転移は見られませんでした。その他、脊柱管狭窄やヘルニアなどの症状も見られず、骨は「とてもきれい!」で、逆に、なぜ、仰向けに寝て足を上げると痛いのかが分かりませんでした。 日常生活では痛みを感じることが無いので、薬も処方せず、他に気になる症状が見られるようになるまでは、放置することにしました。 |
||||||||||||||||||||||||||||||||
| 2022年8月30日(火) |
東邦大学医療センター大森病院にて、胸部CTを撮影し、その後、呼吸器内科の診療を受けました。 この胸部CTは、5月に実施したサイバーナイフ治療がうまく行ったかどうかを確認することが目的です。
左肺の癌は消失していました。成功です。今回は、一回の線量を抑えて施術回数を多くしたためか、前回のような手術痕も見られません。肺にはほかに再発した様子も無く、とりあえず、肺には癌が見られない状態になりました。 それでも念のためタグリッソは継続することになりました。 |
||||||||||||||||||||||||||||||||
| 2022年10月25日(火) |
東邦大学医療センター大森病院にて、呼吸器内科の診療を受けました。 先生が血液検査を入れるのを忘れたため、診察のみでした。私の場合、腫瘍マーカーが当てにならないので、大した影響はありませんが。 体調が変わらない(良い)ことを伝え、タグリッソが処方されました。 |
||||||||||||||||||||||||||||||||
| 2022年11月29日(火) |
東邦大学医療センター大森病院にて、胸部CTを撮影しました。 |
||||||||||||||||||||||||||||||||
| 2022年12月20日(火) |
東邦大学医療センター大森病院にて、血液検査を実施し、呼吸器内科の診療を受けました。 血液検査は正常です。 また、11月29日に撮影した胸部CTも正常で、再発は見られませんでした。 先生はとても上機嫌で、「何か年末の予定はあるんですか?」と聞いてきました。 「特にありません。先生はどうなんですか?」と聞くと、 「久しぶりに長い休みが取れるんです。これで、安心して年を越せますね。」とニコニコしながら言うので、 ニコニコしながら「お前がな」と心の中で返事をしました。 |
||||||||||||||||||||||||||||||||
| 2023年2月17日(金) |
東邦大学医療センター大森病院にて、血液検査、胸部X線撮影を実施し、呼吸器内科の診療を受けました。 血液検査も胸部X線は異常無しです。肺はとてもきれいでした。 仕事の都合で、診察日を火曜日から金曜日に変更してもらいました。その結果、診察室も変わり、火曜日よりも広くなりました。先生の傍らには看護師が座っています。 先生は「金曜日は秘書がいるんですよ~」と上機嫌でした。 |
||||||||||||||||||||||||||||||||
| 2023年4月21日(金) |
東邦大学医療センター大森病院にて、血液検査、胸部CT撮影を実施し、その後、呼吸器内科の診療を受けました。 血液検査は異常無しです。胸部CTに関しては、2022年1月6日に撮影したものと並べて、以下に示します。
左肺(上の図)は、2022年8月30日の画像と若干違うところを見ているせいか、ちょっと施術痕が汚く見えますが、癌はありません。 右肺(下の図)は、サイバーナイフの施術痕に変化はありません。 すなわち、昨年の5月にサイバーナイフの施術をしてから約一年間、肺に癌が無い状態が続いています。先生によれば、現在新しい薬の治験が始まっていて、それが2~3年後には使えるようになるとのことですので、なんとかそれまでは、この状態が続いているといいな、と思います。 |
||||||||||||||||||||||||||||||||
| 2023年6月23日(金) |
東邦大学医療センター大森病院にて、血液検査を実施し、その後、呼吸器内科を受診しました。 血液検査(+尿検査)は異常無しです。 しかし、4月21日のCTを見た放射線科の医師が、「胸骨と左肺との間の軟部組織にある影が気になる」とのことで、急遽、この日胸部CTを撮り、それをもう一度担当医と放射線科の医師とで見て、今後の対応を決めることになりました。結果を聞くのは、次週金曜日(30日)です。 |
||||||||||||||||||||||||||||||||
| 2023年6月30日(金) |
東邦大学医療センター大森病院にて、呼吸器内科を受診し、前週に撮ったCTの所見を聞きました。 「よく見るとですね、3箇所に転移や再発が見られるんです。」 心の中で「最初からよく見てよ。放射線科の医師の指摘が無かったらどうなってたんだよ。」と思いつつ、話を聞きます。 「まず、軟部組織と言っていたのはリンパ節ですね。4月のときよりも少し大きくなってますね。」(下図)
「それから、左肺の胸膜にも転移していると思われます。」(下図)
「さらに、右肺の放射線治療をした近くにも再発しているように見えます。」(下図)
「おそらく、タグリッソはもう効いていないと考えられます。」 心の中で「初めっから効いていないと思っていたから、これは想定内だな。高い薬から解放されるのはいいな。温熱療法も効いていないということかな。」と思いながら、話を聞きます。 「これだけ複数箇所に転移しているとなると、放射線治療は難しいですね。点滴の抗がん剤による治療をお勧めします。今は、入院しなくても通院でできます。」 「どのくらい通院しないといけないんですか?」 「まず、2日連続で通院してもらう必要があります。抗がん剤の点滴をして、次の日に白血球を増やす薬を注射します。それを3週~4週間隔で数回繰り返します。3週にするか4週にするかは、副作用を見ながら決めます。会社の方と相談して日程を決めてください。」 「いつから始める必要がありますか?」 「なるべく早い方がいいですね。7月14日までに日程を決められますか?」 「はい、2週間あれば、決められると思います。」 7月14日の診察で、抗がん剤による治療日程を決めることになりました。なお、この日はタグリッソは処方されませんでした。 |
||||||||||||||||||||||||||||||||
| 2023年7月11日(火) |
これまで処方されたタグリッソは、もったいないので、効かないと分かりつつも飲み続けていましたが、この日ついに飲み終わりました。 |
||||||||||||||||||||||||||||||||
| 2023年7月14日(金) |
東邦大学医療センター大森病院にて、呼吸器内科を受診し、点滴の抗がん剤の治療日程を決めました。 「日程、決まりましたか?」 「はい、副作用がどう出るか分からないので、初回は8月3日と4日、木曜日と金曜日にしようと思います。」 「木曜日は診察日じゃないんですよね」 心の中で「えっ!? それは前回のときに言ってよ! また会社に相談しないといけないのかなぁ、、、」と思いつつ、顔をしかめます。 「金曜日、土曜日ではどうですか?」 「土曜日は大丈夫なんですか?」 「はい、白血球を増やす薬を処置室で注射するだけなんで。」 「それも前回のときに言ってよ!」と心の中で思いつつ、「じゃぁ、初回は8月4日と5日でお願いします。」 「そのあと、3週間隔にしましょうか? 副作用の出方を見て、4週間隔にするかもしれないけど。」 「はい、それでお願いします。以前、オプチーボのようなチェックポイント阻害薬は、単独ではあまり効き目は無いけど、点滴の抗がん剤と併用すると良いと聞いたと記憶しています。今回併用した方が良いのではないですか?」 「いや、抗がん剤と併用しても、20%ぐらいしか効き目はアップしませんね。むしろ、以前使った血管新生阻害薬のアバスチンを使った方が良いので、こちらを併用しましょう。」 「そうなんですね。分かりました。今回使う抗がん剤の具体的な名前はなんですか? これは脳に転移していた場合も効くのでしょうか?」 「ペメトレキセドです。脳に転移した癌にも効きますよ。」 ペメトレキセドは葉酸代謝拮抗薬で、DNA合成に必要な葉酸代謝酵素を阻害し細胞増殖を抑えることで抗腫瘍効果をあらわす薬です。葉酸製剤(製剤例:パンビタン)とビタミンB12製剤を併用して投与します。 「葉酸を補う薬を1週間前から飲んで欲しいので処方しておきますね。タグリッソはどうしてます?」 「火曜日に飲み終わりました。」 「前回処方しませんでしたっけ?」 「はい。」 「リバウンドが怖いので、つまり、タグリッソを急にやめると、癌が急に増殖することがあるので、点滴治療まで飲んでください。処方しますね。」 「前回、ずいぶん抜け漏れがあったな、、、」と心の中で思いつつ、「リンパ節などに転移していると、他のところにも転移していないか調べた方が良くないですか?」 「PETやりますか?」 「はい、お願いします。」 「脳のMRIもやりましょうか?」 「はい、是非。」 診察室をあとにして、会計を済ませ、パンビタン末1週間分が院外処方されていたので、病院前の薬局で購入しました。440円でした。 ここで、タグリッソが処方されていないことに気づきました。あわてて呼吸器内科の受付に戻って、「先生にタグリッソを処方してもらいたい」と受付の人に言いました。他の方の治療中だったためか、処方されるまでかなり待たされました。30分後ぐらいに受付の人に呼ばれ、「診察券を会計に出して会計してください。その後、院内薬局で受け取ってください。」と言われました。 会計で、診察券を提示して会計をしようとしたところ、「自動精算機ではなく人による会計をしてほしい」と言われました。ここでまた待たされます。自分の番号まで10番ぐらいあります。いよいよ次だと思ったときに、なんと、飛ばされます。その後、番号がどんどん先に進みます。これはおかしい、と思い、会計の窓口に行って番号を見せ、「飛ばされたと思います。」と伝えると、担当の男の人は、トレイをガサガサっとして、また次の番号を呼び始めます。「ちょっと、無視しないでくださいよ。この番号、どうして呼ばれないんですか?」と聞くと、今度は、奥の方に行って、他の人と話をして一緒に帰ってきます。もう一度、トレイをあさると、私の番号の伝票が出てきました。この男の人が見落としていたようです。本当にすっとこどっこいばかりの病院です。男の人は、慌てて申し訳なさそうに会計をします。ここまでで更に45分ぐらい経過しました。 やっと院内薬局で薬を受け取ろうとすると、薬局の人が「タグリッソとパンビタン末ですね。」と言います。「いや、パンビタン末は院外薬局で既にもらってますよ」と告げると、「そうなんですね、先生に聞いていみます」と奥に引っ込みます。しばらく経って名前が呼ばれ、「どうやら、一緒に院内でもらえた方が良いかな、と思って院内処方したようです。どうしますか?」と聞いてきます。当然「いらないです」と答えます。「じゃぁ、会計のやり直しですね」ここまででまた30分経過しました。 さらに30分後、この日3回目の会計をしようとすると、「パンビタン末キャンセルで、20円の返金です」と言われます。「いやいや、それはおかしいでしょう。院外薬局では440円しました。同じとは言わないまでも近い金額になるのではないですか?」と言うと、「そうですね。確認します。」と奥に引っ込みます。しばらくして、戻ってきて、「院外薬局でどうしてそのような価格になるのかは分かりませんが、当院の金額は20円です」と言います。「分かりました。それが事実なら、次回から全部院内処方にしてもらいます。」と言って病院をあとにしました。タグリッソの処方をしてもらうために病院に戻ってから2時間半が経過していました。 |
||||||||||||||||||||||||||||||||
| 2023年7月27日(木) |
東邦大学医療センター大森病院にて、脳MRIを撮影しました。 |
||||||||||||||||||||||||||||||||
| 2023年7月28日(金) |
この日から、パンビタン末を服用し始めました。 |
||||||||||||||||||||||||||||||||
| 2023年7月29日(土) |
東邦大学医療センター大森病院にて、PETを撮影しました。 |
||||||||||||||||||||||||||||||||
| 2023年8月4日(金) |
東邦大学医療センター大森病院にて、呼吸器内科を受診し、点滴の抗がん剤を投与しました。 この日から、先生、ボケまくりです。私が座るなり、 「新しいお薬はどうですか?」 「新しいお薬?」 「点滴の抗がん剤。」 「それは今日から投与する予定でしたが、、、」 「、、、ああ、、、そうでしたね、、、何か質問はありますか?」 「パンフレットの副作用のところは読みました。あそこに書いてないことで注意すべきことはありますか? 食事の内容とか?」 「食事は普通に摂れたら摂ってください。吐き気が酷いかもしれないので、吐き気止めを出しておきますね。院内処方で。会社は休めていますか?」 「はい、今日もお休みを頂戴しています。」 「そのほか、聞きたいことは有りませんか?」 「先週、脳のMRIと全身のPETを撮ったと思うんですが、その結果が知りたいです。」 「そういえば、撮りましたね。」とおもむろにファイルにアクセスし始めました、、、 おいおい、大丈夫かぁ、と心の中で呆れます。 「ええっと、脳には転移は無いですね、、、PETはと、、、」と放射線科医の所見と診断を読み始めます。画面に表示されているので、私も覗き込みます。 診断には『左前縦隔リンパ節転移も出現する。横隔膜下には遠隔部病変を疑う腫瘤形成、リンパ節腫大、FDG集積亢進を認めず』と書いてあります。
「要するに、現在肺に見られている転移や再発以外は無さそうですね。」 「良かったです。左肺の胸膜の結節と右肺の再発は光っていないのですか?」 「あれは光るには小さすぎますね。1cmよりも小さいと光らないこともあるんです。」 「それでは、このリンパ節の転移が光らなくなることが今回の治療の目標ですね?」 「そうですね。他に質問はありますか?」 「いえ、特にありません。」 「処置室の場所はご存知ですね?」 「はい。」 「それでは、診察室の前でお待ち下さい。看護婦が書類をお持ちします。」 診察室をあとにして、診察室の前に腰掛けて待っていると、看護婦さんに呼び出されます。 「6番の処置室の前で話をしましょう。」と注射等を行う処置室の前に連れて来られました。 あれれ、外来の化学療法室に行くんじゃないの???と思いつつついていきます。すると、看護婦さんが、 「じゃぁ、まず注射ですね。」 「何の注射ですか?」 「白血球の。」 「白血球を増やす薬の注射は明日のはずなんですが、、、」 「えっ、そうなんですか? 先生に聞いてきます。」 しばらくして戻ってきて、 「明日ですね。まちがって今日に入れちゃったみたいです、、、」 おいおい、大丈夫かぁ、と心の中で呆れます。(この日2回目) 「外来の治療室の場所はご存知ですか?」 「はい。」 「それでは、これをお渡ししますので、一人で行ってください。」 初めっから、そのつもりでしたよ、と心の中で思いつつ、外来の化学療法室に向かいます。 化学療法室で、薬の準備ができるまで、『ペメトレキセド[NK]治療を受ける方へ』というパンフレットを読んでいました。すると、「葉酸とビタミンB12(ペメトレキセドの副作用予防のために必要なお薬)」というページに次のように書いてありました。 ペメトレキセドによる副作用(骨髄抑制・消化器毒性など)の軽減や予防を目的として、葉酸とビタミンB12を投与することが必要不可欠です。葉酸とビタミンB12が投与されずにペメトレキセドが投与されると重篤な副作用が起こる可能性があります。(中略)ビタミンB12は筋肉注射です(筋注ともいわれます)。ビタミンB12はペメトレキセドの投与を始める7日以上前に1回注射します。 あれれ、葉酸はパンビタン末を7日前から飲むように処方されているけど、ビタミンB12は注射してないぞ、、、MRIかPETのときにやるべきだったのではないのかな、、、もう手遅れだけど、薬剤師に確認してみようと思います。 しばらく待つと薬剤師が来たので、パンフレットに書いてあることを示しながら「ビタミンB12の注射を打たずに抗がん剤を投与しても大丈夫なのか?」質問しました。 「そうですね。先生に聞いてきます。」と言って帰っていきました。 おいおい、大丈夫かぁ、と心の中で呆れます。(この日3回目) しばらくして戻ってきて、 「ビタミンB12は普段の食事からも摂取できるので、注射を打たなくても大丈夫です。でも、明日の注射と一緒に打ちましょう。それでどうですか?」 うちの食生活を知らんだろう、、、と思いつつ、1週間後にリスケはできないので、しぶしぶ承諾しました。 その後、血管新生阻害薬(アバスチン)、吐き気止め(ホスアプレピタント)、抗がん剤(ペメトレキセド)を投与しました。最初と最後、そして各薬剤の合間に生理食塩水を投与するので、合計4時間以上かかりました。Kindleで本を読む予定でしたが、途中で眠気に襲われ、ウトウトしてちっとも進みません。また、トイレに3回行きました。 点滴の薬剤の蓋に短いピンを差しているので(下図)、「それは何ですか?」と聞くと、 「薬剤が落ちていくと、凹んで行くんだけど、柔らかい袋じゃないと、だんだん落ちが悪くなるんです。そのために空気を入れるんです。これで。」と説明してくれました。
また、途中で歯科衛生士が来て、口の中を清潔にして欲しい、と言われます。 「葉を磨いていて血が出ますか?」 「いえ、出ません。」 「じゃぁ、今のままで大丈夫だと思いますが、やわらかいのに変えるとかも考えてください。」 「歯ブラシでは出ないんですが、ときどき歯間ブラシも使うんですが、歯間ブラシだと必ず血がでるんです。使わずに洗口液に変えた方が良いですか?」 「洗口液はね、、、あまり役に立たないんですよ。血が出るということはそこにカスが溜まっていることでもあるんで、できれば歯間ブラシもそのまま使ってほしいんです。でも出血はなるべく避けた方がいいので、少しやって出血したら、しばらく待って血が止まるかどうか様子を見て、血が止まるようだったら、先に進んでください。血が止まらないようだったら、しばらく圧迫してください。」 翌日、柔らかい歯ブラシと柔らかい歯間ブラシ(一番小さいサイズ)を買いました。 抗がん剤の投与が終了し、帰路につきます。体調の変化は全く見られませんが、念のためタクシーで帰宅しました。 |
||||||||||||||||||||||||||||||||
| 2023年8月5日(土) |
東邦大学医療センター大森病院にて、処置室で、白血球を増やす薬(ジーラスタ)とビタミンB12(メチコバール)を注射しました。 名前を呼ばれて処置室に入ると、注射器が一本しかありません。 「1本だけですか?」 「はい、白血球を増やすお薬ですよね?」 「ビタミンB12は?」 看護婦が、あわてて、紙の指示書を確認します。 「いえ、今日はこれしか入っていませんね。ちょっと先生に確認しますね。土曜日だけど今日はいるみたいなんで、、、」 おいおい、大丈夫かぁ、と心の中で呆れます。(前日に引き続いて4回目)。自分の身は自分で守るが鍛えられる病院です。 土曜日なので、なかなか捕まらないのでしょう。かなり待たされてます。看護婦の会話が耳に入ります。外国人相手の接客について話しているようです。 「採血室って言っても通じないのよね。」 「そうそう、血を取るところ、って言わないと。心電図とか、困っちゃう。」 とてもいい会話だけど、病院として話し合った方がいいなぁ、と思います。そうこうしているうちに、看護婦さんがようやく戻ってきました。今度は2つのトレイを持っています。 「ビタミンB12も打つことになりました。」 昨日からその予定ですが、、、と心の中で思います。 「それぞれの腕に1本ずつ打ちましょう。ビタミンB12が筋肉注射で、白血球の方が皮下注射です。ビタミンの方を左腕にしましょうか?」 「はい、それでお願いします。」 筋肉注射の方が痛いのかと思いましたが、皮下注射の方が比較にならないくらい痛かったです。 無事終わって、帰路につきます。本当に抗がん剤を投与したのかと思うくらい、体調に変化が見られません。ペメトレキセドのパンフレットには、吐き気が見られるのは「治療開始後数時間から1週間ごろ」、疲労感が見られるのは「治療開始後数日から1週間ごろ」と書かれていますので、1週間は様子を見る必要がありますが。 |
||||||||||||||||||||||||||||||||
| 2023年8月6日(日) |
朝ご飯を食べているときに、右顎の周辺(右耳の下)に違和感を覚えます。何かあるような感じです。 昼ご飯のときには、明らかに腫れて、咀嚼すると痛く、流動食でないと食事が困難になってしまいました。
「気になる症状があれば、休日夜間を問わず、病院に連絡してください。」と言われているので早速病院に電話します。 受付はすぐに出て、金曜日から抗がん剤の治療をしていること、この日から右顎の後ろが腫れて咀嚼すると痛いこと、を伝えると、当直のお医者さんに相談してくれました。 「熱はありますか?」 「先程測りましたら、36.8度でした。私の普段の体温は36度を下回っていますので、私にとっては微熱です。」 「当直のお医者さんがたまたま呼吸器内科の先生で相談したのですが、今日は検査ができないので、熱が高くなければ、明日の朝、呼吸器内科の外来に来てもらった方が良いのでは、とのことですが、いかがでしょうか?」 「それでも大丈夫です。」 「熱が高くなったら、救急でいらしてください。」 「はい。明日の診察はなるべく午前中に受けたいのですが。」 「『午前中の受診を希望している』ことは呼吸器内科の外来に伝えておきます。朝の8:30から9:00の間に呼吸器内科の外来に電話してからいらしてください。」 幸い、この日は熱は上がらず、救急で受診することはありませんでした。しかし、腫れはひどくなり、晩ご飯は、ゼリーとプロテイン飲料にしました。「サプリメントは摂らないように」と言われているので、どちらもビタミンが入っていないものを選びました。 |
||||||||||||||||||||||||||||||||
| 2023年8月7日(月) |
前日に言われたとおり、朝8:30に呼吸器内科の外来に電話をしてから、病院に行きました。 「予約無しなので、多少待っていただくことになりますが、なるべく早く入れるようにします。それから、いつもかかられている先生は今日はいないので、別の先生になります。」 待合スペースで待っていると、私の名前を呼ぶ聞き慣れた声がします。視線を向けると、いつもの先生がいらっしゃいました。 「月曜日しか来られない患者さんがいて、今日はたまたまその人の診察日なんですよ。」 呼吸器内科の外来受付の側の小部屋に案内され、診察を受けます。 「耳下腺炎ですね。耳下腺炎には、ウィルス性、いわゆるおたふくかぜと細菌性があります。実は、今、おたふくかぜが流行っているんですが、症状からすると、これは細菌性ですね。最近、歯の治療とかされましたか?」 「いえ、していません。抗がん剤とは関係ないんでしょうか?」 「直接的な関係はないんですが、免疫力が落ちるので、普通なら症状が出ないものが出た可能性はありますね。抗生物質と痛み止めと消炎剤を1週間分出しますね。院内処方で。」 帰宅して、朝昼兼用のおじやを作って食べ、処方された薬を飲みました。夜には、腫れが若干引き、咀嚼しても痛くなくなりましたので、うどんを食べました。 また、8月4日(金)の血液検査でアミラーゼが390と異常に高かった(正常範囲:44~132)ことを思い出しました。抗がん剤を点滴する前に既に異常があり、免疫力が落ちたことで症状が出たのだろうと思われます。 |
||||||||||||||||||||||||||||||||
| 2023年8月10日(木) |
下の写真では分かりにくいのですが、両鎖骨と胸の上部付近に赤斑があらわれ、若干痒くなりました。
しばらく様子を見ます。 ※この赤斑と痒みは2日間で消えました。 |
||||||||||||||||||||||||||||||||
| 2023年8月13日(日) |
抗がん剤を点滴したところが赤く腫れてきて、触ると痛く感じます。 |
||||||||||||||||||||||||||||||||
| 2023年8月14日(月) |
この日の朝、耳下腺炎用に処方して頂いた薬をすべて飲み終わりました。腫れは引き、硬いものも普通に噛んで食べることができますが、まだ、右耳の奥にモワッとした違和感を感じます。 また、抗がん剤を点滴してから、毎晩就寝中にトイレに起きるようになりました。この日の夜は特にひどく、合計7回起きました。起きるたびにそれなりの量が出ること、昼間の頻度は抗がん剤の点滴前と変わらないことから、前立腺の問題や膀胱の問題ではなさそうです。 |
||||||||||||||||||||||||||||||||
| 2023年8月15日(火) |
抗がん剤を点滴したところの腫れはますますひどくなり、手をダラリと下ろすだけで痛みを感じるようになりましたので、急遽東邦大学医療センター大森病院に電話をして、呼吸器内科を受診しました。 気になる症状は以下の3つです。
いつもの先生がお盆休みでしたので、別の先生に診て頂きました。 まず、耳下腺炎が完全には治り切っていないかもしれない右耳の奥の違和感についてですが、抗生物質をあまり長期間飲み続けるのは良くないので、このまま様子を見て、万が一中耳炎になって、右耳から膿が出てくるようなことになったら耳鼻科を受診することとしました。 次に、夜間の頻尿の件ですが、こちらは抗がん剤とは関係なく、「単なる水の飲み過ぎではないか」とのことでした。 問題は、抗がん剤を点滴したところの腫れと痛みです。こちらは、抗がん剤が点滴中に漏れ出して周囲の組織が炎症を起こしており、放置すると、最悪の場合、壊死してしまうとのことで、急遽皮膚科を受診することとなりました。「壊死」とは、抗がん剤というのはよほどの劇薬だということを改めて認識しました。 皮膚科の診断も同様に「静脈炎」でした。 「ステロイドの注射をします。ものすごく痛いですよ~」とにこやかに言います。 助手の看護婦さんも「100mgでいいですか?」と医師に確認しつつ、「本当に痛いですよ」と追い打ちをかけます。 そして、先生が、腫れた部分に対して放射状に4箇所、ブスッ、ブスッと注射をしていきます。確かに痛い。でも、こちらにも意地があるので、涼しい顔をします。 話はそれますが、同じ大学病院でも診察の仕方は診療科によって異なるようで、皮膚科の診療体制はとても良かったです。皮膚科は3人体制で診察をします。先生は患者と向き合い、説明したり治療を施すことに集中し、その先生の言っていることを、一人の助手の看護婦がカルテに記入していきます。そして、もう一人の看護婦が注射の準備をしたり、施術後にガーゼを貼ったりするなど、先生の治療の補助をします。とても効率的で、一人にかかる時間が短くなります。患者側としても待ち時間が短くなって嬉しいですし、病院にとってもたくさんの患者を診ることができて、経営的にも良いと思います。呼吸器内科にも助手の看護婦が一人いるのですが、診察中は座っているだけで、ときどき、眠そうにしています。 デルモベート軟膏を処方され、1日2回塗り込んだところ、10日で痛みがなくなりました。ただ、注射したところは黒くなり、周囲が固くしこりになりました(下写真)。
|
||||||||||||||||||||||||||||||||
| 2023年8月25日(金) |
東邦大学医療センター大森病院にて、血液検査をして呼吸器内科を受診しました。 血液検査は、肝臓のGOTが37、GPTが50と若干高くなりましたが、それほどひどくないので、このまま抗がん剤の点滴を継続することになりました。 「耳下腺炎はどうなりました?」 「先日まで右耳の奥に違和感を感じていたのですが、今日はそれもありません。これはやっぱり免疫力が落ちたことによるものなのでしょうか?」 「免疫力が落ちた場合、もっとひどい症状になるので、今回は、たまたまこのときになってしまったと考えてよいでしょう。水分補給が足りなかったのではないでしょうか? 水分補給が足りないと唾液の出が悪くなって、耳下腺炎になりやすくなるんですよ。だからもっと水を飲んだ方が良いかもしれません。」 「でも、抗がん剤を点滴してから、夜寝ているときにトイレに起きるようになってしまって、それを先日別の先生に相談したら、『水の飲み過ぎ』って言われたんですよ。」 「そうなんですか? じゃぁ、薬を出しますので、夜寝る前に1錠飲んでみてください。」 「あと静脈炎になってしまって、痛みは無くなったんですが、黒くなって、しこりになってしまいました。」 「これは、そうならないように気をつけるしかないんですよね。特に大きな副作用は見られていないようですので、継続しましょう。」 化学療法室に向かいます。 割り当てられたベッドに寝ていると、最初に歯科衛生士が見に来ました。 「前回から何か変わったことはありますか?」 「実は、左の奥歯が欠けてしまって。ただ、出血を伴う治療はなるべく避けた方が良いかな、と考えて、歯医者には行かずに、よく磨くようにしています。」 「見た感じでは、抜歯をすることにはならなさそうなので、お薬手帳を持って行って、点滴した薬や処方された薬を見せてから治療を受けた方が良いでしょう。」 「今、電子のお薬手帳を使っているのですが、先日、薬剤師の方が、この病院では薬の情報をQRコードで出すことができないって言われて、入力できていないんです。」 「えっ、そうなんですか? 薬剤師に確認します。」 次に、薬剤師がやってきました。 「予算削られちゃって、QRコードを印刷するシステムを導入できなかったんですよ。どうします? とりあえず、紙のお薬手帳に貼るシール形式の情報をお持ちしますので、それを歯医者さんにお見せするのではどうでしょうか?」 IT後進国の片鱗を垣間見た気がしました。 「じゃぁ、それを持ってきてください。手で入力しますので。」 最後に、看護婦さんがやってきて、点滴の準備をします。静脈炎の痕を見て「しばらく左手は休ませた方がいいですね。今日は右手にしましょう。」と言いながら右手を見て、「良い血管が内側に集中しているので、今日は内側にしますね。」と、右手の太い血管から注入する準備をします。 前回は90分かけたアバスチンを今回は60分で点滴することになり、30分時間が短くなったはずですが、始まりが遅かったのか、結局病院を出たのは3時過ぎでした。 |
||||||||||||||||||||||||||||||||
| 2023年8月26日(土) |
東邦大学医療センター大森病院の処置室にて、白血球を増やす薬(ジーラスタ)を皮下注射しました。 また、夜になって、目がシバシバするようになり、鏡を見ると、目が充血して、目ヤニも大量に出ていました(下写真)。
ここで1クール目を振り返ろうと思います。 まず、体温と血圧です(下図)。体温は、平熱が若干上昇した気がします。加えて、耳下腺炎と静脈炎がひどいときに37度近くの微熱がありました。また、以前、アバスチンを点滴したときには血圧の上昇が見られましたが、それが今回はまだ見られません。
次に、白血球、赤血球、血小板の数です。赤血球数は若干減っていますが、白血球数と血小板数は増えています(下図)。
最も心配されていた、吐き気、食欲不振は全く見られません。そのため、体重に変化は見られません(下図)。
ただ、内臓への影響は皆無ではなく、タグリッソのときと同程度の下痢が見られます(下図)。
抗がん剤=脱毛というイメージがありますが、今のところ、それは見られません(下図)。
それから、抗がん剤を点滴してから、夜中に尿意を覚えて起きるようになりました(下図)。これに関しては、医師は「そんな副作用は聞いたことがない」と言っていますが、、、
※25日(金)の夜に尿対策として処方されたソリフェナシンコハク酸塩OD錠を1錠飲んでから就寝しましたが、夜中に1回起きました。 |
||||||||||||||||||||||||||||||||
| 2023年8月28日(月) |
毎日夕食前に約2.5km散歩をしていますが、この日の散歩のあと、貧血気味になり、頭がボーッとするようになりました。 |
||||||||||||||||||||||||||||||||
| 2023年8月29日(火) |
貧血の症状が酷くなり、倦怠感も覚えるようになり、デスクワークにも関わらず、1時間働いては15分休むという感じに、時々ベッドで横にならないと、仕事ができない状態になりました。 食欲も落ち、酸辣湯麺のような煮麺を作ってもらって食べ、早めに就寝しました。 |
||||||||||||||||||||||||||||||||
| 2023年8月30日(水) |
前日よく休んだのがよかったのか、貧血の症状は弱くなり、いつものペースで働けるようになりました。 |
||||||||||||||||||||||||||||||||
| 2023年9月3日(日) |
前回(1クール目)は、点滴の約1週間後に点滴痕が腫れ痛くなりましたが、今回は、腫れたり痛くなったりしませんでした。しかし、点滴をしたところから肩の方向に静脈が赤黒く変色しました(下図)。
|
||||||||||||||||||||||||||||||||
| 2023年9月15日(金) |
東邦大学医療センター大森病院にて、血液検査、胸部X線撮影をして呼吸器内科を受診し、その後、抗がん剤の点滴(3クール目)を実施しました。 診察などの内容とともに、2クール目までを振り返ります。 まず、声のかすれです。最初(1クール目)の点滴時、喉がかゆくなり、点滴後から声がかすれ、ハスキーボイスになってしまいました。処置室は冷房が効いていますので乾燥のせいかと思い放置していたら、1週間ぐらいで元の声に戻りました。ところが、2クール目も同様に点滴中に喉がかゆくなり、点滴後から声がかすれるようになりましたので、抗がん剤の点滴との関連性を疑うようになりました。喉は全く痛くありませんので、たまたま風邪が重なったというわけではなさそうです。しかも、今回は、この日まで3週間かれっぱなしで、元にもどりません。先生に、ハスキーボイスで経緯を話し、抗がん剤との関連性を聞いてみました。 「抗がん剤と一緒に投与している吐き気止めの副作用ですね。処置室の薬剤師さんにも聞いてみてください。」 いつも点滴を始める前に、薬剤師の問診がありますので、薬剤師さんにも同様に経緯を話し、関連性を聞いてみました。 「吐き気止めの副作用ではないですね。声のかすれは『嗄声(させい)』と言うのですが、その記述はありません。『咽頭炎』はありますが、喉は痛くないんですよね? 分かりませんね。」 声がかすれたまま3クール目を実施しますので、抗がん剤や吐き気止めの影響かどうかは分からなくなってしまいますが、しばらく様子を見るしかなさそうです。 次に、夜中に尿に起きるようになった件です。ソリフェナシンコハク酸塩を処方され、飲みましたが、下図のとおり、むしろ悪化してしまいましたので、飲むのをやめました。
この経緯を先生に話しましたが、「そうですか、、、困りましたね、、、」とおっしゃるだけですので、「最近は、一晩に一回程度に落ち着いてきたので、我慢します」と言って、この件は終わりにしました。 処置室の薬剤師さんにも同様の説明をしたところ 「抗がん剤や吐き気止めの副作用にはないですね。夜起きるので、寝不足で困っていますか?」 「いいえ、トイレに起きてもすぐにまた寝ますので、寝不足にはなっていません。」 「ソリフェナシン以外にも夜間の尿に対する薬はいろいろありますので、寝不足などで困った場合は、泌尿器科を受診すると良いかもしれませんね。」 とアドバイスをもらいました。 また、2クール目は、耳下腺炎にはなりませんでしたが、点滴後3日目から5日目にかけて、倦怠感と貧血の症状に悩まされました。これは、よく発生する副作用のため、我慢するしかなさそうです。 体温を見ると、やはり、抗がん剤を投与した翌週は体温が上がるようです。
血液の成分としては、赤血球は若干下がり気味ですが、異常値ではありません。ただし、グラフにはしていませんが、ヘモグロビン濃度も同様に低下して、正常値の下限ギリギリアウトという感じになりました。白血球は、注射が効いているのか増加傾向にあります。
倦怠感をおぼえてもなるべく食べるようにしていたせいか、体重は変化無しです。
下痢は減ってきたように感じます。
問題は静脈炎です。2クール目は、点滴の2日後に静脈が赤くなりましたが、それ以上腫れたり痛くなったりすることはありませんでした。しかし、5日後には、片方が赤黒くなり、それが定着してしまいました。やはり、血管にダメージが残っているようです(下図)。 「何とか4回はやりたいところですね。4クール目の前にCTを撮って、抗がん剤の効き目を見てみましょう。」 ということになりました。今回(3クール目)も最後から2番目の抗がん剤の点滴を始めると点滴箇所が痛くなり、その後生理食塩水に変えると痛くなくなりますので、薬剤そのものの刺激によるものと考えられます。抗がん剤治療は「毒をもって毒を制す」「肉を切らせて骨を断つ」というような治療なんだな、ということを改めて実感しました。
脱毛は見られません。
|
||||||||||||||||||||||||||||||||
| 2023年10月6日(金) |
東邦大学医療センター大森病院にて、血液検査+尿検査、胸部CTを撮影して、呼吸器内科を受診し、その後、ビタミンB12の筋肉注射、抗がん剤の点滴(4クール目)を実施しました。 一番気になるのは胸部CTの結果です。
リンパ節に転移した腫瘍(黄色い丸)は、だいぶ小さく薄くなりました。4クール目で更に小さくなると思われますが、完全には消えない可能性があります。「維持療法」と言って、抗がん剤の種類を減らして、白血球数がなるべく減らないようにしつつ、抗がん剤の点滴を長期間継続する治療法もあるそうですが、体への負担も大きいので、一旦4クールで終わりにすることを先生に勧められ、そうすることとしました。 血液検査の結果も悪くありません。一時上昇していたGOTもGPTも正常範囲の少し上のあたりまで低下してきました。 4クール目の点滴以後は、5週間後の次回の診察までパンビタン末を服用し、経過観察に移ることになりました。 「明日は、白血球を増やす薬の注射ですね。」 「ペメトレキセドの説明書には、ビタミンB12の筋肉注射を9週ごとに1回注射と書いてあります。明日が9週目だと思うのですが、、、」 「そうでしたね。では、その予約も入れておきますね。いつも通り、看護婦さんが抗がん剤の処方を書いた紙を持ってきますので、前(待合スペースのこと)で待っていてください。」 待合スペースで待っていると、看護婦さんがやってきました。 「では、これから注射ですね?」 「何の?」 「ビタミンB12の。」 「明日じゃないんですか?」 「今日で指示が入ってますね。」 「白血球を増やす注射は?」 「それは明日ですね。抗がん剤を打ってから24時間以上空けた方が良いので。」 「そうなんですか?」(初めて聞いたよ、、、今までは大丈夫だったのか?) 「はい、ですから、抗がん剤を打ち終わったら、明日何時に来れば良いか、看護婦さんに聞いてください。」 抗がん剤を打ち終わるのはいつも午後3時頃ですが、明日は午前診療ですので、24時間空けるのは難しいと思われます。でも、この看護婦さんが言っていることが本当かどうかも分からないので、抗がん剤の処置室で改めて聞いてみることにしました。ビタミンB12の注射を打って、処置室に向かいます。 ここで、第3クールまでを振り返ります。 体温は、抗がん剤の点滴の2~3日後から上がりはじめ、普段よりも0.3~0.5度高い状態がしばらく続きます。それと同時に倦怠感と貧血の症状が現れ、熱が下がると、症状も無くなります。
血液の成分としては、赤血球が徐々に減って、正常範囲を下回りました。
体重は変化無しです。
下痢は減ってきています。
静脈のダメージは相変わらずで、今回は肘に近いところに打ったためか、肘を曲げ伸ばしするたびに痛みを感じる状態が2週間続きました。
前回、処置室の薬剤師さんには「抗がん剤や吐き気止めの副作用には無い」と言われた夜間頻尿ですが、下のグラフのように、抗がん剤の点滴の3日目ごろから、体温が上がるに連れて回数が増えていますので、明らかに関連があるように思われます。そこで、下のグラフを印刷して見てもらうことにしました。
ところが、薬剤師さんが前回の方から変わっていて、どうも新人のようで、グラフを見せても「私の今の知識ではお答えできませんので、次回までに勉強しておきます。」と言うばかりです。「しばらく次回はないんだよなぁ、、、」と思いつつ、「それではお願いします。」と言っておしまいにしました。 次に、看護婦さんがやってきて、私の顔を見るなり、「温めなくちゃいけないんでしたね」と言いました。1クール目に静脈炎を起こしてから、2クール目からは、血管を広げるために、点滴前に湯たんぽみたいなものを腕に置いて、温めることをしてきました。 めんどくさくなったのか、「ちょっと見せてください。」と言いながら、腕を見て、「今日は大丈夫そうね」と言いつつ、細い血管をトライをしました。でも、うまく行きません。 「やっぱり温めるのかなぁ」と思いましたが、やはりめんどくささが勝ったのか、「太い血管使いますね。」と言って、あっさり血液検査でも使う太い血管に点滴を刺しました。温めて細い血管を使っても、そこから先の血管にダメージがあるので、どこを使うのが良いのか、よく分かりません。
抗がん剤の点滴は、いつも通り午後3時に終わりました。帰り際に事務所にいる看護婦さんに、「明日、白血球の注射を打つんですけど、何時に来院すれば良いですか?」と聞いてみました。 看護婦さんは、ポカンとしています。そして、おもむろに「私には分かりませんので、先生に聞いてみますね。この先の待合室で待っていてくれませんか」と言いました。 しばらくして、看護婦さんが待合室にきて、「もしかしたら後日にリスケするかもしれないので、呼吸器内科の受付に戻って聞いてみていただけますか?」と言います。仕方なく、呼吸器内科の受付に戻ります。 呼吸器内科の受付まで戻って名前を告げると、最初に「来院時間を処置室の看護婦さんに聞け」と言った看護婦さんが出てきて、 「24時間空けた方がいいんですが、明日は1時までしか開いていないので、12時から1時の間ぐらいに来てくれますか?」 「だろうね。それにしても今まで大丈夫だったんですかね。」と言いたいところでしたが、ただ「分かりました」と返しました。 |
||||||||||||||||||||||||||||||||
| 2023年10月7日(土) |
東邦大学医療センター大森病院にて、白血球を増やすジーラスタの皮下注射を打ちました。 抗がん剤の処置室の薬剤師さんには、「抗がん剤や吐き気止めの副作用には無い」と言われた嗄声ですが、やはり抗がん剤を打ってから酷くなりましたので、念のため録音しました。 |
||||||||||||||||||||||||||||||||
| 2023年10月14日(土) |
この頃から、咳が出るようになりました。 肺からの咳ではなく、喉の咳で、特に食事中から食事後に出ることから、抗がん剤によって胃酸が喉まで上がってきているのかもと考えましたが、吐き気はまったく感じないので、逆に、抗がん剤と一緒に投与している吐き気止めの影響ではないかと考えています。嗄声とも関連しているかもしれません。 |
||||||||||||||||||||||||||||||||
| 2023年10月19日(木) |
この頃から、右膝の裏が痛くなりましたが、特に腫れているわけではありません。 数日で痛くなくなりました。 |
||||||||||||||||||||||||||||||||
| 2023年10月31日(火) |
左足の中指を、硬い椅子の足にぶつけました。 |
||||||||||||||||||||||||||||||||
| 2023年11月5日(日) |
火曜日にぶつけた左足の中指を、もう一度ぶつけました。激痛で悶絶しました。 |
||||||||||||||||||||||||||||||||
| 2023年11月7日(火) |
近所の整形外科で、左足の中指を見てもらったところ、見事に骨折していました。
1週間ほどでくっつく見通しです。 |
||||||||||||||||||||||||||||||||
| 2023年11月10日(金) |
東邦大学医療センター大森病院で、血液検査、胸部X線撮影を実施し、呼吸器内科の診察を受けました。 血液検査では、一時上昇していた肝臓の数値は、ほぼ正常範囲まで戻ってきました。また、赤血球数が減ってきていることを指摘すると、「ヘモグロビン濃度が下がってきていないので大丈夫」とのことでした。
胸部X線に関しては特に問題は見られませんが、抗がん剤の投与を始める前に見られた左胸膜と右肺に見られた再発が、抗がん剤の投与の結果、どのように変化したかを確認しました。4コース実施前に撮ったCTでは、左胸膜に見られた再発は小さくなってはいますが、完全には消えていません。
そこで、左肺のリンパ節と胸膜に関しては、サイバーナイフで切除を試みることにしました。横浜市東部病院は改築工事をしていましたが、ちょうど11月から再開したそうです。「以前照射したところと近いとできない場合もありますが、それも含めて診てもらいましょう。」と紹介状を書いてもらうことになりました。 その他、気になっていることとして、4クール目から、咳が出ることが多くなったことについて聞いてみました。 「食事中や食後によく出るので、抗がん剤か吐き気止めの影響ではないでしょうか?」と持論を展開しましたが、 「考えにくいですね。季節の変わり目だからじゃないでしょうか。」と取り合ってくれません。 嗄声と関連しているのではないかとも考えているのですが、これ以上議論しても無駄だと思い、突っ込みませんでした。以下に11月11日の声を示しますが、まだ少ししゃがれています。 その他、抗がん剤の投与による変化を以下にまとめます。 4コース目から血圧が若干上昇してきています。
4コース目から体重も若干上昇してきています。
下痢は減ってきています。これは、分子標的薬をやめたからと思われます。
夜中に排尿に起きるようになったのは、抗がん剤の投与をやめてからも続いています。
静脈炎に関しては、すっかり良くなり、痕も見られません。 このあと、整形外科にはしごして、左足中指の骨折の包帯を取り替えてもらいました。 |
||||||||||||||||||||||||||||||||
| 2023年11月15日(水) |
東邦大学医療センター大森病院に書いてもらった紹介状を持って、横浜市東部病院に行きました。 サイバーナイフの治療のスケジュールの作成が目的でしたが、そこまで至りませんでした。7月29日(土)に撮ったPETで、左肺胸膜に再発した癌が光らなかったことが原因です。 放射線科の先生がこう言い始めました。 「PETの画像を見る限り、リンパ節の方は分かるんですが、左肺の胸膜の再発がどこにあるか、分からないんですよね。」 「左肺の胸膜に再発した癌はPETでは光らなかったんです。東邦の先生は『小さすぎて光らない』って言っていました。」 放射線科の先生は、本当?という感じで、少し顔をしかめます。 「10月に撮ったCTを見れば分かると思うのですが。」 と言うと、10月に撮ったCTを見て、「これですか?」と聞いてきます。 「それではなくて、もう少し平べったい盛り上がりです。」 というようなやり取りを何度かしたあと、 「どうでしょう。紹介状には、文章しかなくて、画像を示して腫瘍の箇所が分かるようになっていないので、このままでは、誤ったところに照射してしまう可能性があります。その場合、当てるべきところに当たらず、当てるべきないところに当てることになってしまいます。そこで、こちらで改めてCTを撮って、画像を見る専門家に見てもらって、それからスケジュールを立てるのではいかがでしょうか? 場合によっては金マーカーを設置しないといけませんし。」 とてもリーズナブルな判断なので「それでお願いします」と返答しました。 それからなんとか当日中にCTを撮ってもらえるように調整してくださったので、CTを撮ってから帰宅しました。 |
||||||||||||||||||||||||||||||||
| 2023年11月22日(水) |
横浜市東部病院の放射線科を受診しました。 前の週に撮ったCTを専門の技師に見てもらった結果、左肺のリンパ節への転移と左肺の再発の2箇所を特定することができました。 金マーカーを設置する必要があるかどうかを判断するために、もう一度CTを撮った結果、それほど動く場所ではないため、金マーカーを設置せずに実施することとなりました。 問題は日程です。2箇所に3日間ずつ照射するため、連続6日(営業日)休みを取得する必要があります。仕事のスケジュールを見ながら、1月29日から2月5日で実施することとしました。また、2ヶ月後とだいぶ先なため、状況が変化している可能性を考慮し、念のため、1月17日にCTを撮ることとしました。 |
||||||||||||||||||||||||||||||||
| 2023年12月15日(金) |
東邦大学医療センター大森病院にて、血液検査、尿検査、胸部X線撮影のあと、呼吸器内科を受診しました。 血液検査において、看護婦さんが採血を終えて腕のゴムバンドを外そうとしたときに、採血用の管に手を引っ掛けて、針先が大きく動きました。止血用のテープを貼ってもらって歩きだすと、腕を伝って血がポタポタと落ち始めました。それを見つけた病院の関係者が「貼り直し、貼り直し」と叫びます。別の人が「4番、4番」と叫んで、連れて行かれたブースは、元の採血ブースでした。止血用のテープを外してみると、内出血しています。でも、看護婦さんは何食わぬ顔で、淡々とテープを貼り直し、「はい、どうぞ」という顔でこちらを見ます。文句の一つでも言ってやろう、と思っていましたが、なんとなく、何も言わずにその場をあとにしました。 血液検査の結果そのものは、特に異常はありませんでした。 サイバーナイフの日程が決まりましたので、次回は、サイバーナイフ後の2月16日にCTを撮ることになりました。 |
||||||||||||||||||||||||||||||||
| 2024年1月17日(水) |
11月15日にサイバーナイフの予約時にCTを撮ってから日がだいぶ空くため、状態が変わってないかを確認するために、横浜市東部病院でCTを撮りました。 CTを撮ったあと「会計をしてお帰り下さい」と言われたので、「診察は無いのですか?」と尋ねると、「診察をご希望ですか?」と逆に聞かれました。 「状態が変わっていないか、予定通りサイバーナイフを実施することができるのか、確認したいです。」 「でしたら、そこでしばらくお待ち下さい。」 しばらくして、名前を呼ばれ、診察室に入ると、放射線科の先生が立っています。私も立ったまま「どうでしたか?」と聞くと、 「まだ画像が送られてきておらず、お見せすることができないんです。でも、画像を確認した技士からは『どこに癌があるか分からないくらいおとなしくしている』と報告を受けているので、29日から予定通り実施しましょう」と言われました。 一安心です。 |
||||||||||||||||||||||||||||||||
| 2024年1月29日(月)~2月5日(月) |
サイバーナイフを実施しました。 内容は前回と同じですが、幾つか変わったことがありました。
つつがなく終わったのですが、初日は若干ドキッとしたことがありました。 施術中、いきなりサイレンが鳴り渡り、「ただいま、駐車場で火災が発生しています。ご来院の皆様は、次のアナウンスをお待ち下さい。」とアナウンスがありました。続けて、「本館には影響はありませんが、引き続き、アナウンスにご注意ください。」とか、「業者の方は、至急お車までお戻り下さい。至急お車を移動してください。消防車が地下駐車場に入れません。」とか、騒々しい中で施術が続きます。しばらくすると、機械が止まり、放射線科の人が施術室に入ってきて、「アナウンスがうるさいと思いますが、本館には影響は無いとのことですので、このまま続けますね」と言います。その後もひっきりなしに状況を伝えるアナウンスを聞きながら施術を受けました。 施術を終え、会計を済ませて、病院を出ると、外には多数の消防車が停まっていました。救急車も停まっています。「この救急車は怪我人をどこに運ぶんだろう?」と考えながら病院をあとにしました。 |
||||||||||||||||||||||||||||||||
| 2024年2月16日(金) |
東邦大学医療センター大森病院で、血液検査・尿検査、胸部CT撮影を実施し、呼吸器内科の診察を受けました。 血液検査は異常無し。 胸部CTの画像でサイバーナイフの結果を確認します。
サイバーナイフの施術から10日しか経っておらず「すぐに消えて無くなるわけではない」とのことですので、4月にもう一度CTを撮ることになりました。その日程を決めようとしたときに、先生からご自身の異動についてお話がありました。 「実は、4月から佐倉病院勤務になるんです。でも、土曜日は大森に来ることもあるので、次回の診察からは土曜日にしたいのですが、いかがでしょうか? 抗がん剤の投与など平日しかできない施術もあるので、他のお医者さんに代わってもらうこともできるのですが、できれば継続して診た方が良いと思うのですが。」 この先生は「名医」という感じではないので(失礼)、他の先生に代わっても状況が悪化することはなさそうです。でも、責任感からなのか、診続けたいと考えていらっしゃるようですので「土曜日で構いません」と答えました。 次回は4月27日(土)になりました。土曜日の場合、CTの予約をすぐに入れることができないようでしたので、「空きはあるので、あとで入れておきますね」という言葉に「だいじょうぶかなぁ」と不安に感じつつ、診察室をあとにしました。 |
||||||||||||||||||||||||||||||||
| 2024年4月27日(土) |
東邦大学医療センター大森病院に行きました。前回の不安が的中し、CTの予約が入っていません。用心のためにかなり早めに行っていたので、とりあえず血液検査と尿検査を済ませて、呼吸器内科の受付に行き、CTの予約が入っていないことを伝えました。案の定、先生が予約するのを忘れていたので、すぐに緊急で入れてもらい、無事CTを撮ることができました。 そして、そのCTで異常が見つかりました。 「首のリンパ節に転移しているようですね、、、」(下図)
昨年10月6日のCTにはありませんので、この半年で現れたものです。 サイバーナイフで施術した箇所は、前回の診察と同様、
ので、今見えている範囲では、この新たなリンパ節への転移をどうするかがもっぱらの課題です。しかし、他にも転移している可能性がありますので、PETを実施することとなりました。PETの結果、
を実施することになりそうです。PETは5月25日(土)に実施することになりました。ほかに転移がないことを祈るばかりですが、その点に関し、先生が気になることを言っていました。 「腫瘍マーカーのCEAが上昇しているんですよね、、、」(下図)
この腫瘍マーカーは血管新生阻害薬(アバスチン)投与時に上昇したり、肺に腫瘍があっても上昇しなかったりしますので、あまり当てにならないのですが、確かになぜ最近上昇し始めたのか、気にはなります。分子標的薬の服用をやめたことが関連しているのでしょうか、、、 ここで、他の指標と抗がん剤や分子標的薬との関連性を見ておきたいと思います。 まず、GOTとGPTは、抗がん剤投与期間に若干上昇しています。
夜間頻尿は、抗がん剤投与期間は見られ、抗がん剤の投与をやめてからしばらく経つと見られなくなりました。
下痢は、分子標的薬服用期間、および、抗がん剤投与期間中は見られましたが、両方ともやめてからは見られなくなりました。
温熱療法に関しては、効いているのかどうか、定かではありませんが、お金はそれほどかかりませんので、これからしばらくは首まで浸かるようにしてみようと思います。 |
||||||||||||||||||||||||||||||||
| 2024年5月25日(土) |
東邦大学医療センター大森病院でPETを実施しました。 今回は、最初の薬剤の注入で手間取りました。 左腕に点滴の管を挿入しようとするのですが、なかなか血管にヒットしません。看護婦さんが「おかしいなぁ」と言いながら、方向を変えて何度も抜いたり挿したり、グリグリッと回転したりするので、痛覚的にはそれほど痛くはないのですが、視覚的に痛くなってきて、思わず顔をしかめてしまいます。あまりにもうまく行かないので、左腕がぐちゃぐちゃになりそうに思え、「腕を変えませんか?」と提案して、右腕に変えたところ、すんなり挿入することができました。左腕の方は後日アザになりました(下写真)。
あとは「いつもどおり」のプロセスを実施し、無事帰宅しました。 |
||||||||||||||||||||||||||||||||
| 2024年6月1日(土) |
東邦大学医療センター大森病院で、血液検査と尿検査を実施して、その後、呼吸器内科を受診して、前の週に実施したPETの結果を聞きました。 血液検査の採血後、パッチの上から指で抑えて止血しているときに、パッチの下から血がポタポタと滴り落ちて来たので、あわててパッチを張り替えてもらいました。そのとき「血液サラサラの薬、飲んでますか?」と聞かれました。このときは、それほど気にしなかったのですが、数日後、同じことを聞かれることになろうとは、、、 血液検査と尿検査は異常無し。PETの所見は以下のとおりです。 左上葉肺癌術後、術創部局所に明らかな腫瘍・結節、FDG集積亢進出現なし。 ※FDGとはフルオロデオキシグルコースというブドウ糖によく似た分子構造をもち、陽電子というものを放出する性格をもった薬剤で、活性化している癌細胞に取り込まれ(集積し)、PETで光ります。
要するに、転移は左鎖骨上窩リンパ節のみでした。 そのため、予定通り、サイバーナイフで治療することとなり、紹介状をもらって帰宅しました。 |
||||||||||||||||||||||||||||||||
| 2024年6月11日(火) |
東邦大学医療センター大森病院からの紹介状を持って済生会横浜市東部病院に行きました。 受付で待っているときに、後ろの夫婦と思しき二人が終始ゲホゲホしているので、「うつされませんように」と祈りながら並んでいました。 今回は、呼吸器内科の受診は不要で、ダイレクトに放射線科を受診することになりました。医師は、前回とは異なる方でした。 「PETの写真を見ましたけど、一箇所だけで、胸水も無く、良い状態ですね。すぐに始めても良さそうです。全部で5回やりましょう。」 「一箇所なのに5回ですか?」 「はい、近くに左手を動かす神経が通っていて、放射線を神経に当てすぎると、半年から一年後に左手がしびれたり、握力が低下したりする恐れがあるので、慎重にやりましょう。」 「連続5日間でないと駄目ですか? 前回はそのように言われました。」 「いいえ、連続している必要はありませんよ。時間は30分から40分ぐらいだと思います。」 人によって言うことが変わるなぁ、と思いつつ、日程を決めます。6月26日、27日、28日、7月2日、3日になりました。 「今日、顔と肩を固定するマスクを作っていきましょう。」と見本のマスクを示します。剣道の面のようです。 「それから造影剤を入れてCTを撮りましょう。」 CTの部屋に案内されます。 まず、上半身裸になって、CTのベッドの上に仰向けになると、上から透明で無数の穴の空いた蒸しタオルのような温かい感触の物体を顔と肩に押し当てられます。冷えてコチコチになるまで待って、取り外したあと、造影剤の注入に移りました。看護婦さんが針を挿してしばらくすると、「あらっ」と言って慌てだします。 「アル綿とって!」と言って、私の右腕を拭きつつ、「血液サラサラの薬、飲んでませんか?」と聞いてきました。作業しているところが視界には入らず、顔を横に向けて様子を見るのもはばかられるため、目で確認できないのですが、使用しているアル綿の量から察するに、大量の血が漏れ出ているようです。これがトラブルの始まりでした。 腕を載せている台や床の血を拭き終わったところで、いよいよCTの撮影が始まりました。さきほど作ったマスクを顔に乗せ、パチン、パチンと音を鳴らして固定します。顔や肩が正面から圧迫されます。そして、造影剤を注入し始めました。右手、右足、右側頭が急激に熱くなります。いつもより、右半身が急激に熱くなるように感じました。そして、右手がパンパンに腫れるような感覚を覚え、激しく痛くなりました。 「痛い、痛い! 右腕が痛い!」と叫んで、造影剤の注入を停止してもらいました。すると痛みが少しずつ収まります。中止かな、と思っていたら、しばらく休んで症状が収まりきったところで、また注入が再開されました。そして、また激しい痛みに襲われます。渡されていたブザーを鳴らして、「痛い!痛い!」と足をジタバタさせます。 やっと造影剤の注入は中止されましたが、ある程度の量が入ったためか、「どうする?」「撮っちゃいましょう」という会話が聞こえたあと、「少し大人しくしてください」と言われ、CTの撮影は続行されました。 右腕の痛みは無くなりましたが、造影剤を注入した管を抜き取っているときに、なぜか左半身だけが震え始めました。寒くないのに、歯がカチカチと言い始めます。そのうち、全身が細かく震え始めました。 放射線科の医師が呼ばれ、バイタルが計測されます。数値は見えませんが、血圧が150まで上がっているようです。血中酸素濃度は99%、脈拍は60前後と落ち着いています。 体を起こし、診察衣の上着を着けて、水をコップ一杯飲むと、震えが止まってきました。 症状が落ち着いてきたので、着替えて排尿し、診察室の前で座っていると、低血糖を疑っている医師がキットカットを持って来ました。意識ははっきりしていたので、低血糖ではないと思いましたが、ありがたく頂戴して、特に異常は見られないので、帰宅しました。 医師の診断はアレルギー反応とのことでしたが、私は、医療過誤、注入圧が高すぎてそれが右脳に何らかの影響を与えたのではないかと考えています。 |
||||||||||||||||||||||||||||||||
| 2024年6月26日(水) |
この日から7月3日(水)まで、正味5日、済生会横浜市東部病院にて予定通りサイバーナイフを実施しました。 今回は、事前に作ったマスクを使って、頭部と肩を固定しましたので、毎回施術後は下図のようにマスクの穴の痕がつきました。
|
||||||||||||||||||||||||||||||||
| 2024年7月6日(土) |
今日、左手でものをつかもうとすると左手に痛みを感じました。サイバーナイフの副作用としては早すぎるので、別の原因でしょうか、、、 |
||||||||||||||||||||||||||||||||
| 2024年8月31日(土) |
東邦大学医療センター大森病院にて、血液検査、尿検査、胸部CT撮影を実施し、呼吸器内科を受診しました。 血液検査、尿検査は異常無し。先生は、上昇傾向にあったCEAという腫瘍マーカーが前回の3.4から1.5に下がったことを喜んでいました。私は腫瘍マーカーを信じていないのですが、悪い気はしません。 胸部CTでは、サイバーナイフを施したリンパ節を確認しましたが、大きさが半分ほどになっていました(下図)。「放射線の効果は半年ぐらいは持続するんです。今後さらに小さくなると思われますので、引き続き経過観察しましょう」ということになりました。
「またリンパ節に転移するとしたら次はどこですか?」 「転移するリンパ節の位置がだんだん上に上がってきているので、首ですね。」 「じゃぁ、首にしこりができないか、注意しておけばよいのですね?」 「喉が痛くなっても腫れるので難しいけれど、次回のCTから首のリンパも見るようにしましょう。」 次回は、11月9日(土)に、またCTを撮ることにしました。 「そうそう、新しい抗癌剤が治験が終わって、今承認プロセスに入っています。順調に行けば半年後の来年の4月ごろには使えるようになるでしょう。」 (以前、先生が別の遺伝子変異向けの抗がん剤の状況を勘違いされていたことがあったので)「それは、私の遺伝子変異にも効果があるものですか?」と確認すると「そうだ」とおっしゃるので、期待して良さそうです。早く承認されて、実際に効き目があることを祈ります。 |
||||||||||||||||||||||||||||||||
| 2024年11月9日(土) |
東邦大学医療センター大森病院にて、血液検査、尿検査、胸部CT撮影を実施し、呼吸器内科を受診しました。 血液検査、尿検査は異常無し。CEAという腫瘍マーカーは前回と同じ1.5でした。また、サイバーナイフを実施する直前の6月1日の血液検査ではCEAの値が5.7まで上昇していたことが知らされました。この腫瘍マーカーはあまり当てにならないと思っていましたが、意外と当てになるのかもしれません。 サイバーナイフを施したリンパ節は、形が崩れてきているようです。(下図)。また、首のリンパ節にも転移している兆候は見られません。ただ、いずれもはっきりとは分かりませんので、念のため、次回はPETを実施することとしました。
「今は何も飲んでいないんですよね?」と先生。 「はい、4月には新薬が出るんですよね?」 「ええ、タグリッソが効かなくなった患者さんにも効くそうです。でも副作用、特に皮膚への副作用が激しいようなので少量から始めましょう。当院第一号になると思います。」 |
||||||||||||||||||||||||||||||||
| 2025年2月1日(土) |
東邦大学医療センター大森病院にて、PETを実施しました。 薬剤が全身にいきわたるように、薬剤を注入してから、ペットボトルの水を飲みながら安静にするのですが、以前は、
と言われていたのが、いつのころからか「おしっこは我慢しなくていいですよ」と言われるようになり、今回、「水は飲みきらなくていいですよ」と言われました。 薬剤が変わったのか、測定技術が上がったのか。 |
||||||||||||||||||||||||||||||||
| 2025年2月8日(土) |
東邦大学医療センター大森病院にて、血液検査、尿検査を実施し、呼吸器内科を受診しました。 下図に前週のPETの画像を示します。(上段が今回、下段が前回(2024年6月1日))
所見は以下のとおりです。 右上葉肺癌術後、術局所に再発を疑う病変は認めない。 昨年サイバーナイフを実施した箇所はきちんと消失しています。また、リンパ節への転移を繰り返していましたが、耳下のリンパ節などへの新たな転移は見られません。 血液検査・尿検査も異常無しです。 このまま経過観察で、3ヶ月後にCTを撮ることになりました。 |
||||||||||||||||||||||||||||||||
| 2025年5月24日(土) |
東邦大学医療センター大森病院にて、血液検査、尿検査、胸部CT撮影を実施し、呼吸器内科を受診しました。 すべて異常無しです。 「落ち着いていますね。」と医師。 「去年は2度もサイバーナイフをやっているので、半ば信じられません。」 「肺には、治療の痕がたくさん見られますが、癌らしきものは無いですね。首のリンパも大丈夫そうです。新しい薬が無事認可されたのですが、それは、転移が見つかって、対処不能なときに使うこととしましょう。しばらくは経過観察で。」 CTは半年に一回として、3ヶ月後に胸部X線と血液検査を実施することになりました。 ずっと熱めの風呂に浸かることを継続しているためか、最近、平均体温が36度を超えるようになってきました。こうした体質の変化が関連している気がします。 |
||||||||||||||||||||||||||||||||
| 2025年8月23日(土) |
東邦大学医療センター大森病院に行きました。自動受付機で受付を済ませ、血液検査のために、すぐわきの階段を登ろうとすると、自動受付機の音声案内の「どの課を受診されますか?」という女性の声に、タッチパネル式の自動受付機に向かって「皮膚科、皮膚科を受診したい」と連呼している男性の声が聞こえました。「幸あれ」と念じながら階段を登りました。血液検査では、看護師さんの腕が悪く、針を刺しても血が出てこず、何度も刺し直して血管を探すので、次第に痛くなってきました。さすがに「人を代えて欲しい」とは言えず、別の場所でトライしてもらいました。尿検査では、前に採尿した人が、採尿管を置くトレイごと持っていってしまったようで、受付に向かおうとしところで、慌てて返しに戻ってきました。暑さのせいでしょうか。今日はいろいろあるなぁと思いながら、胸部X線撮影を実施し、呼吸器内科を受診しました。診察では、首のリンパ節に転移がないか、触診で確認してもらいました。 すべて異常無しです。胸部X線の画像を以下に示します。
「うれしいですけど、なんの服薬も無しで一年以上再発も転移も無いのは気持ち悪いですね。」 というと、次回は首から腹部まで造影剤を用いたCT撮影を実施することになりました。 |
||||||||||||||||||||||||||||||||
電子化が医療崩壊を(多少)救う
2020年5月11日 Nippon News Network(NNN)のニュースより。
都の感染者 111人報告漏れ、35人重複
東京都が毎日発表している新型コロナウイルスの感染者数について、小池知事は、保健所からの報告に111人の漏れなどがあったと発表しました。
東京都は、区や保健所などから報告を受けて、新型コロナウイルスの感染者数を毎日、発表していますが、小池知事はインターネットのライブ配信で、複数の保健所からの報告に、現時点で111人の漏れと35人の重複があったと発表しました。
都では、保健所などが端末に入力した感染者の情報を、紙で報告を受けていますが、その紙が届かなかったり、二重で報告されていたということです。
都は現在、集計をやり直していて、感染者の総数は、これまでよりも増えるということです。担当者は、「入力システムが統一されていないことや、保健所の業務がひっ迫していることが原因」と説明しています。
保健所に、端末で入力したデータを集計して印刷して都に送付している人がいる。逼迫している状況で、そんな作業をさせておきながら、一方で「医療崩壊だ」と騒いでいる。都庁にも、紙で受け取ったデータを入力し直して、集計している人がいる。抜けも重複も分からないような稚拙な集計で間違いを犯し、再集計までしている。
私が都に納めている税金は、こんなアホな作業のために使われていたのか、、、。電子化のために使って欲しい。電子化すればこれらの作業はすべて無くなる。
まぁ、e-Taxもクソみたいなひどいシステムで、納税のためにいらぬ手間を使わせるので、税金を有効に使うという発想が納税段階から欠落しているのだが、、、。そういえば、マイナンバーカードもトラブル続きだし、東京オリンピック・パラリンピックのチケット申し込みサイトも当初はひどいものだった(こちらは後日だいぶ改善された)。電子化するにしても、政府や地方自治体など公共機関に対する営業組織を持っている会社の出入りを禁止して、フリーランスの集合体にでも作らせた方が良いかもしれない。